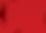

![]()


Last Friday, volunteers gathered at Rivers Edge Park in Clyde to plant rivercane along the banks. The project is part of a larger master plan created by Haywood Waterways Association to protect the area from future flooding. (Page 22) Holly Kays photo
News
Cullowhee Valley retires controversial mascot ..........................................................4 Dog park coming to Cashiers ..........................................................................................5
High demand for pro-bono legal services during COVID ......................................6 Equal Rights Amendment introduced in N.C. ............................................................8
Bi-partisan opposition builds against Rep. Cawthorn ..............................................9 Cashiers developer offers last-minute plan reduction ..........................................10 Haywood vaccinations surge, other counties lag ..................................................12 Community Almanac ........................................................................................................15
Opinion
D ESIGN & PRODUCTION: Jessica Murray.
ADVERTISING SALES: Susanna Shetley. .
Amanda Bradley. .
Hylah Birenbaum. . .
Sophia Burleigh.
C LASSIFIEDS: Scott Collier. . . . . . . . . .
N EWS E DITOR: Jessi Stone. .
WRITING: Holly Kays. .
Hannah McLeod. . .
Cory Vaillancourt.
Garret K. Woodward. . .
ACCOUNTING & O FFICE MANAGER: Amanda Singletary. .
D ISTRIBUTION: Scott Collier. .
jessica.m@smokymountainnews.com
susanna.b@smokymountainnews.com
jc-ads@smokymountainnews.com
hylah@smokymountainnews.com
sophia.b@smokymountainnews.com
classads@smokymountainnews.com
jessi@smokymountainnews.com
holly@smokymountainnews.com
. hannah@smokymountainnews.com
cory@smokymountainnews.com
garret@smokymountainnews.com
smnbooks@smokymountainnews.com
classads@smokymountainnews.com
C ONTRIBUTING: Jeff Minick (writing), Chris Cox (writing), George Ellison (writing), Don Hendershot (writing), Susanna Shetley (writing) Boyd Allsbrook (writing)
WAYNESVILLE | 144 Montgomery, Waynesville, NC 28786
P: 828.452.4251 | F: 828.452.3585
SYLVA | 629 West Main Street, Sylva, NC 28779 P: 828.631.4829 | F: 828.631.0789
I NFO & B ILLING | P.O. Box 629, Waynesville, NC 28786 Copyright 2021 by The Smoky Mountain News.





























BY HANNAH MCLEOD STAFF WRITER
Cullowhee Valley School will no longer be represented by the Rebel mascot, which is personified by an old, white, Confederate general.
After two rounds of public comment in opposition to the mascot, and a petition with over 900 signatories, the Jackson County School Board decided during a Tuesday, Jan. 26, meeting to discontinue use of the controversial name and symbol.
Cullowhee Valley School had used the Rebel mascot since 1958, four years after the Brown v. Board of Education Supreme Court decision that deemed school segregation illegal. In 1994, when the Camp Lab school closed and Cullowhee Valley School opened, there was some discussion within the community about changing the mascot, but ultimately, CVS remained the Rebels.
Over the past year, CVS graduates in Jackson County and around the country wrote letters to school board members and started a petition to engage the Jackson County community. They also began fundraising efforts for new signage and renovations needed if a new mascot could be decided on and created education platforms in support of a new mascot.
was an eighth grader at CVS. At that time, the image of the rebel colonel was prominent in the school, painted on the walls in the gym, lunchroom and hallways. Her daughter now attends CVS and, McCord says, the image is more toned down these days.
McCord was one of the organizers of the group “retire the rebel,” that restarted the
tion to the Jackson County School Board.
Speaking to the board during that October meeting Wilson said, “there is much that could be said, but I wish to keep it simple. The rebel mascot divides. An inclusive environment requires a non-controversial mascot that all CVS students can cheer for.”
Emily Virtue, a parent at Cullowhee Valley
The motion stated that the mascot, name and logo at CVS be discontinued and that the students at CVS be permitted to select a new logo by no later than the start of the 20212022 school year. The timeline and process for selection by the student body will be left to the discretion of the superintendent and the administration of CVS.
“The timeline and process for selection of the new mascot and logo will be established in the coming months by the superintendent and school administration,” said Superintendent Dr. Tony Tipton.
Following the decision to discontinue the rebel mascot, McCord stated the importance of next steps.

At the school board meeting Tuesday night, Kelley Dinkelmeyer spoke in support of retiring the mascot. Though she is not from Jackson County, she says, she grew up immersed in Southern culture. She said that in speaking to her daughter and her daughter’s friends, who attend CVS, she knows that many of the students there see the mascot as a symbol of hate.
“It’s not really a mascot, it’s a piece of adult nostalgia,” said Dinkelmeyer.
Annie McCord Wilson previously campaigned to change the rebel mascot when she
movement to change the mascot last year.
“I think that the cultural and political climate recently, gave us a good platform to encourage us to help the community make this change. There has been lots of awareness recently about racial injustice. People are confronting those parts of ourselves that we don’t really like to confront, and people are educating themselves about implicit bias and ways that, even without thinking, we could be acting in a way that’s discriminatory or making other people feel uncomfortable,” Wilson told SMN last October after she presented the peti-

and a professor of education leadership, presented the petition with McCord.
“It is not an image of pride. It is an image of power and divisiveness. It reminds us that at one time, white power over black people was valued and keeping this mascot we continue to send that same message, at least implicitly, that we value the concept of power over black people, more than we value black people themselves,” Virtue said.
The decision by the board to discontinue the Rebel mascot on Jan. 26 passed with a unanimous vote.
“Moving forward, for now I think it’s important to take a beat,” said McCord. “There are a lot of people in our community who are grieving the loss of this mascot that has been in the school for almost 70 years. I think it is really important to take some time and allow people to process, and, moving forward respectfully. I think it’s really important that we keep that in mind as we move forward. And I know that the administration at the school is definitely on that same page and wanting to have a respectful retirement for the rebel.”
Because there are such broad implications to changing the mascot for a school, the “retire the rebel” group has been fundraising for several months now to provide economic assistance for the change. The group hopes that the process of changing the mascot can be a learning experience for CVS students.
“We’ve been doing fundraising, we have over $1,100 at this point and we’re still counting every day. So that’s great, to kind of help offset the cost of some of these changes,” said McCord. “I have contacts for supporters of the rebel who I hope to be able to work with moving forward and creating some preservation and kind of framing the rebel in a historical context, which I think is important for community members, but also for the students as a learning experience for the students to understand why this decision was made and why there are people who support keeping the rebel and people who support getting rid of it.”

BY HOLLY KAYS STAFF WRITER
Cashiers will get a dog park following the Jackson County Commissioners’ unanimous vote Jan. 26 to approve a contract with Vision Cashiers allowing the park to be built between the two baseball fields on the Jackson County Parks and Recreation Department Complex off Frank Allen Road.
“Our goal for the Cashiers Dog Park is to establish a fenced-in, off-leash dog park where canine citizens and their owners can exercise and socialize in a clean and safe environment while respecting people, property and wildlife,” Rand Kramer, the Cashiers resident who spearheaded the effort, said in a Dec. 16 press release. “This is an important community need that is currently missing in our beloved Cashiers.”
Kramer first approached Vision Cashiers with his idea in spring 2020, and in less than a year the organization raised the money and garnered the approval from county leaders needed to make it happen.
“This is a win-win collaboration between Cashiers and the county,” Paul Robeshaw, co-founder of Vision Cashiers, said in the same press release. “We are excited to turn this dream into a reality for the residents of Cashiers and their four-legged friends.”
Jackson County manages the land in question under a long-term lease with its
A Franklin man who pleaded guilty last week to trafficking in methamphetamine has been sentenced to serve 70 to 93 months in prison.
Franklin Officer Randy Dula arrested Matthew Scott Winters, 27, after spotting a car on Jan. 13, 2020, using windshield wipers, but not headlights; additionally, the right headlight was missing.
Winters was a passenger in the car that was northbound on Georgia Road.
The officer turned his patrol vehicle from the southbound into the northbound lanes, near Belden Circle. He said the driver increased speed, changed lanes and quickly turned into a fast-food restaurant’s parking lot. Dula followed.
While speaking to the driver, he smelled the odor of marijuana coming from the car.
In Winters’ black backpack, Franklin police discovered folded tinfoil with a pill inside that had burn marks; a baggie with 1.83 grams of marijuana and rolling papers; a can of WD-40 with a false bottom that contained 32.39 grams of methamphetamine and various drug-related paraphernalia, including a glass smoking pipe and a large flat metal spoon.
Judge Mark Powell sentenced Winters in Macon County Superior Court. Assistant District Attorney Jason Arnold prosecuted the case.
owner, the Cashiers Valley Community Council. The 40-year lease began in September 2004 and ends on July 1, 2044.
Under the terms of the contract, Vision Cashiers will contribute $50,000 for the dog park’s construction, which it raised with donations from more than 130 people.
While the county intends to maintain the dog park for as long as it leases the property, it is contractually obligated to do so for only 10 years. If the county needs the property for another purpose before 10 years are up, it will have to foot the bill for moving the dog park to a “nearby or similar facility.” Once construction wraps up, the county will own the dog park, not Vision Cashiers.
Vision Cashiers is a volunteer nonprofit whose goal is to solve problems and guide the growth of Cashiers. The organization, while still fairly new, has a long list of accomplishments, including working with partners to build a medical clinic set to open this spring or summer, installing public WiFi in the Cashiers commercial area and distributing 500 facemasks to area businesses. Commissioners’ Jan. 26 vote represents its second agreement with Vision Cashiers over the last two months. On Dec. 15, commissioners unanimously approved a resolution agreeing accept ownership of and maintain the sidewalk network that Vision Cashiers is working to fund in the Cashiers commercial area.
The Haywood County Tourism Development Authority has announced the timeline for the 1% and 3% Grant Program for the 2021-22 budget year.
To be eligible for funding, new applicants must attend a virtual partnership funding workshop at 10 p.m. Feb. 10 or 2 p.m. Feb. 11.
Applications for 1% funding must be submitted to the TDA Office by 5 p.m., Wednesday, March 31. Applications for 3% funding must be in by 5 p.m. on April 16.
Haywood County Commissioners have appointed three-person subcommittees in each zip code area to review applications and make funding recommendations for the HCTDA board’s final approval. The purpose of 1% zip code funding is to encourage the advertising and marketing for each zip code destination and promotion of special events that showcase the unique character of Haywood County and attract visitors from beyond a 50-mile radius.
Partnership funding is available for promotional and tourism related projects and events. Not-for-profit and for-profit organizations may apply. For-profit organizations must match the award dollar-for-dollar.
Funding Guidelines and applications can be found online www.haywoodtda.com beginning Feb. 10. For more information, contact the HCTDA office at 828.944.0761.






written by Ingles Dietitian Leah McGrath
Recently I got asked what are my "cheat" foods. I'm not a fan of using the word "cheat" when it comes to food; it makes me think of being sneaky by eating "bad" foods. Words matter.
Treat foods may be foods that are rich-high in fat or high in sugar-that you really wouldn't want to eat on a regular basis. Treat foods may be ones that are more expensive or hard to find so they're only eaten for special occasions. Treat foods may be ones that are labor intensive to make or prepare so when you do eat them, you savor and enjoy them.
You aren't bad for eating these foods and these foods aren't necessarily "bad" for you.
Your "treat" foods may be French fries or French toast ... sweetbreads or just sweets like candy or chocolate...or maybe cinnamon rolls or Alaskan King crab legs. For some Eggs Benedict may be a "treat" but scrambled eggs are something they eat several times a week.
Let's stop talking about foods in a binary, good/bad way and appreciate food that nourishes our bodies. Let's be thankful we have the ability to provide food for ourselves and our families.
Let's try and help others who aren't quite as fortunate by donating



BY J ESSI STONE N EWS EDITOR
As people continue to struggle through the COVID-19 pandemic, the demand for pro-bono legal services has spiked, putting more demand on nonprofit legal organizations like Pisgah Legal Services and Legal Aid.
Pisgah Legal Services, which opened an office in Highlands/Cashiers last year, and Legal Aid, which has had an office in Sylva for decades, have seen a hefty increase in call volumes from people needing free legal representation in civil matters. And more people out of work means more people are eligible for the free services.
“So many low-income people are eligible for our services in Western North Carolina — well over 200,000 people were eligible last year and last year we helped 22,000 people, which is a record. So already we’re not able to meet the need,” said Jim Barrett, executive director of Pisgah Legal Services. “And in this pandemic, a lot of people have fallen into poverty and have recently become eligible for services, and all this happened really suddenly.”
The nonprofits are able to help people with a host of civil legal matters, but the vast majority of the work during the pandemic has been surrounding domestic violence, housing, Social Security benefits, unemployment claims, unfair debt collections and health coverage.
“We’re helping people stabilize and secure affordable housing, helping them access affordable health insurance to get the health care they need, helping people avoid domestic violence and child abuse or escape from it, and we’re helping people increase their income to come out of poverty,” Barrett said. “In the pandemic, the emphasis has shifted to unemployment and housing issues. We’re seeing more situations where people are losing income and needing health insurance coverage because they’ve lost a job.”
Suzanne Saucier, the managing attorney of the Smoky Mountains Legal Aid office based in Sylva, has worked for the organization since 2010. She interned at the Sylva office in the summer of 2009 and loved it so much she decided to come back to the area after she graduated law school to continue her work with the nonprofit.
“Our mission is basically to bring legal justice to those who can’t afford it,” she said. “When you think of providing legal services for people who can’t afford an attorney, I think most people think of public defenders, but that’s on the criminal side of the law. We offer services on the civil side of the law.”
While Saucier has eight attorneys, three paralegals and one healthcare navigator who work in this area, she also has the expertise of the statewide Legal Aid network.

Legal Aid and Pisgah Legal have worked on more eviction cases in the last year as more people are unable to pay rent. Temporary regulations during the pandemic gives renters some leeway when it comes to paying their rent. However, landlords can still evict a tenant for reasons not associated with COVID-19. Eviction cases are also still being heard in court.
“We’re trying to help people have a safe home. There may be conditions the landlord is not fixing in the home or fair housing discrimination cases,” Saucier said. “We’re trying to keep families in a physically and emotionally safe environment so we work on domestic violence cases as well.”
The Centers for Disease Control and Prevention plans to extend the eviction moratorium through March 31. Gov. Roy Cooper has already extended his state eviction order to March 31, assuring the CDC order still applies in N.C.
Saucier said it’s important for tenants to understand the moratorium is not a blanket moratorium — landlords can still go through the eviction process for certain reasons. She encourages tenants to download the Affirmative Action form on the Legal Aid website to provide a copy to their landlord.
“Know that your landlord can’t change your locks or turn off your electricity without going through the court process,” Saucier said. “Since it’s not a total moratorium, landlords have gotten smart about ways to get around these things.”
On the other side of that, Barrett said other landlords have been working with their tenants, understanding the financial struggles people are going through right now even though they may be struggling to pay their own mortgages on rentals.
“Having those resources statewide and being able to make a big impact for everyone in North Carolina because of our reach across the state — that’s something that’s been such a plus during all this,” she said.
Staying connected to lawyers in other parts of North Carolina and staying informed has been critical during the pandemic as COVID-19 regulations and protocols seem to be changing daily.
Barrett said Pisgah Legal is averaging more than 1,000 calls a day — sometimes more than 1,400 calls a day — from people seeking advice. About 30 percent of those calls are from people who can be referred to Pisgah’s Mountain Area Volunteer Lawyer program (MAVL). About 300 attorneys volunteer to assist Pisgah Legal clients today. In 2017 alone, WNC attorneys donated 3,176 hours, a value of $794,083.
Pisgah and Legal Aid have both seen a major increase in domestic violence cases across the region. With more people out of
work and isolated together at home, emotional and mental stress is high, which has led to an increase in domestic violence incidents. Even though much of the court system hasn’t been operating during the pandemic, domestic violence cases are still being heard.
“We’re very fortunate in our part of the state none of our agencies had to shut down so we’ve worked closely with them through the pandemic as they continue to provide services,” Saucier said. “And even when the courts shut down these kinds of cases continued.”
Even though the cases are still being heard, Barrett said court system delays have still been an issue because of social distancing requirements and cases having to be spread out.
“The courts are scheduling things farther out and farther apart, and I think the results of that are going to be all over the place. In some cases it might have made people quit litigating and start talking to each other and in other cases justice has been delayed for people,” Barrett said. “In many cases justice wasn’t possible because the money for relief hasn’t come yet.”
A recent research study that came out of Duke University showed the eviction moratorium is reducing incidents of COVID — information lawyers have been able to use in court as one argument for keeping their client in their home. There are plenty of other reasons though, including the scarcity of long-term rental properties in WNC.
“Even when we’re not talking about COVID, moving is hard for everyone whether you have resources or not and when you don’t have resources it’s that much more difficult,” Saucier said. “Imagine having a child doing remote learning and then trying to move and get all that set back up. Not to mention uprooting a family from their home can be traumatic.”
Then there’s the foreboding issue of home foreclosures — something Barrett and Saucier say is their main concern moving into 2021.
“I’m dreading the flood of foreclosures I see coming,” Saucier said. “There are some protections in place and mortgage companies are willing to work with people on for-

People have a new opportunity to enroll in health insurance for 2021 on HealthCare.gov, but only for a limited time.
This new COVID-19 Special Enrollment period starts on Feb. 15 and ends on May 15. Pisgah Legal Services, Legal Aid and Mountain Projects all have health care navigators on staff and are once again offering free assistance helping people review their options and sign up for ACA health insurance.
With job losses continuing to mount amid the COVID-19 resurgence, and millions of people having lost their job-based health insurance since the start of this public health and economic crisis, the Biden Administration has opened up HealthCare.gov to give people who need health insurance a new opportunity to get covered, but they must act quickly.
If you can’t afford a lawyer and have questions about your rights as a tenant or landlord, ACA health care coverage, unemployment or Social Security benefits, not receiving your stimulus checks, unpaid utilities or mortgages or any other COVID-19 related matters, you might qualify for free legal representation through Pisgah Legal Services or Legal Aid. Both organizations serve people in the western counties.
• Pisgah Legal Services — Serves Macon and Jackson counties. Call 828.210.3404 or visit www.pisgahlegal.org.
• Legal Aid of NC — Serving all counties west of Buncombe. Call 828.586.8931 or visit www.legalaidnc.org
bearances right now, but it’s only delaying the inevitable. Banks have held off on those, but when they get the green light I think across the state we’re going to see foreclosures happening.”
Once the COVID regulations are lifted, homeowners will be no better off than they were when the pandemic hit and will only be further behind on their payments.
“We’ve been urging people to pay their rent or mortgage if they can and as much as they can because the more they get behind, the more likely they are to be displaced when the moratorium ends,” Barrett said. “You have to make a good faith effort to pay what you can and that’s what’s been difficult about our work — helping people find the assistance they need to do that.”
He added that many people have already spent their savings during this eco-
nomic downturn and some have even had to dip into their retirement to stay afloat. When that happens, Barrett said he definitely worries about more foreclosures happening in 2021.
“We’re just waiting for that other shoe to drop,” he said. “We are wondering how patient are the banks going to be?”
With the federally insured loans, Barrett said the government keeps extending the deadline for people to extend their mortgage terms into the future so they don’t get behind. Mortgage holders that aren’t federally insured aren’t compelled to renegotiate terms with people, and Barrett said he’s heard some of those lenders are already starting foreclosure proceedings.
Pisgah Legal and Legal Aid are both encouraging WNC residents to check their websites regularly for updates to COVIDrelated legal issues and useful forms people may need.
Legal Aid services all seven counties west of Asheville while Pisgah Level Services serves Jackson and Macon counties in addition to counties east of Asheville. Pisgah recently opened an office on the Plateau to serve Highlands-Cashiers, though lawyers have been working remotely from home during the pandemic.
Both organizations also have specific programs that focus on the rights of seniors — helping with estate issues, Social Security and/or unemployment benefits and elder abuse cases. Legal Aid also works in the tribal courts on the Qualla Boundary handling adoptions and parents custody cases.
The nonprofit does not offer sliding scale services — only free services for those who meet the poverty level requirements,
“More than 535,000 North Carolinians enrolled in a health insurance plan during the last Open Enrollment period,” said Shannon Cornelius, Pisgah Legal’s Health Justice Program Director. “This is a new chance for people to sign up, and anyone who needs health insurance should visit HealthCare.gov today, or contact Pisgah Legal Services if you need assistance. Don’t delay.”
Health insurance is more affordable than many people think. In North Carolina, 83 percent of current marketplace consumers had plans available for 2021 that cost less than $50 per month, after financial help. Nine out of 10 marketplace enrollees in North Carolina received financial help that lowered their monthly health insurance premiums last year. In addition, 57 percent of enrollees also qualified for lower out-of-pocket costs for health care services.
“Many people can find good deals on HealthCare.gov and receive financial assistance to help lower their monthly health insurance costs,” said Plummer. “We help guide our clients through that process,” said Jan Plummer, certified application
although there are exemptions when it comes to elderly and domestic violence cases.
Barrett said Pisgah has been fortunate to receive some additional funding from various sources to help with specific issues during COVID, including CARES Act funding to hire a lawyer to work on elder law issues and a grant from Dogwood Health Trust to hire someone to work on housing issues and to help people sign up for the Affordable Care Act, which is having an extended enrollment period.
Pisgah Legal doesn’t receive any state funding, something that still boggles Barrett.
“We get more funding from Buncombe County than we do from the state. The General Assembly leadership doesn’t put a
counselor program coordinator with Mountain Projects.
Consumers enrolling in a plan on HealthCare.gov are guaranteed to receive comprehensive coverage, with no preexisting condition exclusions or markups. All plans cover essential benefits, including doctor and hospital visits, prescription drugs, mental health treatment, and maternity care. In addition, consumers receive free preventive care services, such as immunizations and health screenings. Testing and treatment of COVID-19 are considered essential health benefits and are covered by all HealthCare.gov plans.
Consumers should avoid insurance plans offered outside of HealthCare.gov that seem too good to be true. “Junk insurance” products and short-term limited duration plans pose huge financial risks to consumers. These products can refuse to pay for care for pre-existing conditions, charge consumers more based on their gender, and impose annual coverage limits.
“HealthCare.gov is the only website where North Carolina consumers are guaranteed to get comprehensive coverage,” said Cornelius.
Jim Barrett, executive director of Pisgah Legal Services, said a navigator can help people find the best plan for them and also explain how the federal subsidies work.
“”It’s terribly complicated the way the subsidy works — it’s on a sliding scale so you have to anticipate your income to determine how much you’ll pay for your premium,” he said. “And you have to be above the poverty line to qualify because North Carolina didn’t expand Medicaid so we have this Medicaid gap.”
Make an appointment at pisgahlegal.org/aca or call 828.210.3404. Make an appointment with Mountain Projects by calling 828.452.1447 or visit www.getcoveredwnc.com/get-in-touch to find your local contact.
Make an appointment with Legal Aid at 828.586.8931 or visit www.legalaidnc.org.
priority on it. I don’t know if they don’t know how important of a safety net we are or they’re just indifferent,” he said. “We used to get $7 million a year, but since the recession it’s just kept going down. We’ve had to raise money from private sources and donations, but you never know how long that’s going to last.”
Legal Aid, on the other hand, received federal funding in addition to state funding and private donations/grants. Legal Aid’s entire state budget is about $28 million.
If you are looking for resources, the best first call to make is 211. That line can connect you with food, heating and other assistance through government agencies and nonprofits.
BY C ORY VAILLANCOURT
P OLITICS E DITOR
More than 40 years after it first took up the matter, the North Carolina General Assembly may consider finally ratifying the Equal Rights Amendment first passed by Congress in the early 1970s.
“The Equal Rights Amendment symbolizes the unpacking of equality. We’re in this space right now where we’re talking about equality and what it means to be an inclusive society,” said Dr. Ameena Zia, a Mills Riverbased social impact consultant and appointed United Nations representative at ECOSOC, the Economic and Social Affairs Council, since 2015.
Last summer, Americans commemorated the 100th anniversary of the ratification of the 19th Amendment, which finally gave women the right to vote. Last fall, they saw the first woman — and woman of color — elected to the office of the Vice President.
“We know that intersects all economic and social dimensions, including public health, labor, wages, education, violence, and safety. Given the current political atmosphere, which does reflect very polarized policy with heightened divisions between beliefs and ideologies, especially across North Carolina, I feel like right now is an important time for us to start having this conversation.”
The proposed amendment would serve as “an essential constitutional guarantee for correcting systemic sex discrimination in North Carolina and nationally, since it would affirm that constitutional rights are held equally by all persons regardless of sex, it would provide a fundamental legal remedy against sex discrimination, and it would make ‘sex’ a suspect classification, so that governmental actions that treat people differently based on sex would have to bear a necessary relation to a compelling state interest,” according to N.C. House Bill 8.

There are several processes by which amendments to the U.S. Constitution can become law. The path chosen for the ERA in 1970 by Michigan Rep. Martha Griffiths was to seek approval in both the U.S. House and Senate. Such a measure would need to pass by a two-thirds majority, and in 1972 it did, before a quick signature by President Richard Nixon made it official.
But that wasn’t the end of it — the proposed amendment then needed to be ratified by legislatures in three-fourths of the states. By 1977, 35 states had ratified it. Another six states, South Carolina, Oklahoma, Florida, Louisiana, Missouri and North Carolina, approved the proposed amendment, but in one legislative chamber only.
During that timeframe, five states that had previously ratified the proposed amendment subsequently rescinded their ratifications: Idaho, Kentucky, Nebraska, South Dakota, and Tennessee. There is, however, much debate over whether or not the states had the power to do so.
Furthermore, when originally passed by Congress, the Equal Rights Amendment had a sunset clause — if it wasn’t fully adopted by the states before March 22, 1979, it could no longer be considered for ratification.
Both of those roadblocks are actually just speedbumps, according to HB 8, filed on Jan. 27, 2021 by primary sponsors Julie von Haefen (D-Wake), Carla Cunningham (DMecklenberg), Susan Fisher (D-Buncombe) and Evelyn Terry (D-Forsyth).
As to the sunset issue, Congress extended the 1979 deadline to 1982. In February 2020, the U.S. House further extended (or rather abolished) the deadline, stating that the amendment “… shall be valid to all intents and purposes as part of the United States Constitution whenever ratified by the legislatures of three-fourths of the several States,”
however the U.S. Senate hasn’t passed its companion bill.
Nevertheless, Nevada, Illinois and Virginia all ratified the proposed amendment between 2017 and 2020.
As to the recissions advanced by Nebraska, Tennessee and others, North Carolina’s bill says that state withdrawals of amendment ratifications have never been valid.
“That would be a mess,” Zia said. “As we have seen with this particular amendment, having states able to rescind amendments creates chaos. It creates that division of ideology, a division of beliefs.”
Western North Carolina’s Senator Kevin Corbin (R-Macon) wasn’t a sponsor of HB 8’s companion bill in the Senate, SB 15, sponsored by Valerie Foushee (D-Chatham), Natasha Marcus (D-Mecklenberg) and Natalie Murdock (D-Durham). Corbin didn’t respond by press time to a request for comment.
Likewise, none of Western North Carolina’s three House reps, Mike Clampitt (R-Swain), Karl Gillespie (R-Macon), and Mark Pless (R-Haywood) signed on as sponsors to the bill.
“First, let me say fundamentally I agree equal rights should apply to everyone,” Gillespie said, before noting the expiration dates and recissions as problematic. “I think we would need clear guidance on these two points to determine what exactly will this bill do if passed and if this bill is not passed, based on the impact of what has happened since this was taken up by Congress.”
Clampitt hadn’t yet read the specifics of HB 8 due to an emergent situation in the NCGA involving the Catawba tribe’s proposed casino in King’s Mountain, and Pless said he didn’t see a need for the amendment’s approval or dismissal, since the requisite number of states had already ratified it — implying his acceptance of the extension of the expiration dates and the unconstitutionality of the recissions. But much like his stance on Haywood County’s so-called Second Amendment sanctuary resolution last year, Pless doesn’t believe that rights emanate from a piece of paper.
“There will always be the assertion that women are treated differently, paid differently and are being held back by the man. My mother, wife and all the other female members of my family have never been kept from being successful because they happened to be born female. I have had the privilege in my
lifetime of knowing very successful business women, female business owners, female nurses, female doctors, female firefighters, female police officers, female military veterans, female attorneys, female judges and this list goes on,” he said. “Life is what we make of it and a lot of times the easiest way to justify not being successful is by blaming someone else instead of ourselves. We have to many real issues in North Carolina to deal with to waste time on a political statement that will not make a difference in the ERA getting ratified or not getting ratified.”
In Haywood County, the leaders of the two major parties — both women — held predictably different stances on the ERA.
“I’m very conservative when it comes to adding amendments to the U.S. Constitution. Thankfully, U.S. women have achieved much since the 1970s,” said Kay Miller, Haywood Country Republican Party chair. “Almost all of the concerns the ERA was to ‘fix’ have been remedied so I don’t see a need for that particular amendment today and I wouldn’t support NC ratifying the amendment.”
Myrna Campbell, chair of the Haywood County Democratic Party, still thinks the ERA is necessary — now more than ever.
“Bills to ratify the ERA have been filed in the NC General Assembly every year since 2015, but none have been brought to the floor for a vote or even allowed a committee hearing,” Campbell said. “Even in times of Democratic leadership, NC’s history of dealing with women’s issues is not good, so passing the ERA legislation would be a step forward in reversing that trend. More and more women are running for office and 2018 was a historic election for women candidates. In short, women are helping to reshape America’s leadership and we need equal footing within the legal systems of all 50 states.”
Zia agrees with Campbell, saying it would be another important step for North Carolina to take.
“We’re in the midst of a global pandemic,” Zia said. “How we come out of the pandemic, our response and recovery effort is certainly going depend on how we are able to project our society towards inclusion. I think from that point of view, right now is the time for this amendment to be passed. And I would love to see it pass in North Carolina’s General Assembly. I think it would set the tone for North Carolina moving forward.”



BY C ORY VAILLANCOURT
P OLITICS E DITOR
He hasn’t even been in office for a month, but Western North Carolina’s Republican Rep. Madison Cawthorn is already starting to see groups forming to oppose him over his conduct leading up to the Jan. 6 insurrection.
“Republicans would like to simply move on,” says the Republican Accountability Project’s website. “But without accountability there is no clear path forward. That is why we’ve launched the Republican Accountability Project.”
The project aims to support congressional Republicans who “at great personal and political risk, are defying party leadership and defending the institutions of our republic,” and also to unseat elected officials that supported overturning the Nov. 3 General Election.
That explains the billboards popping up in Buncombe and Henderson counties, and their simple message. “You lied about the
machine, and are one of the top ‘dark money’ groups in the 2020 election cycle according to election financing watchdog, Open Secrets. Rep. Cawthorn will continue to work hard for the people of his district, and will continue to fulfill his promises of only representing their interests, not the interests of some D.C. lobbying group.”
But large national PACs aren’t the only ones expressing their displeasure with Cawthorn. In early November, just after the election, Buncombe resident Nicolette Baglio started another group, called Women Invest Now — N.C., on Facebook.
“Madison’s kind of the first order of operation for us, trying to get him removed if we can,” Baglio said. “I think that a couple of the House members, Greene, Boebert and Cawthorn potentially, could be expelled from Congress and I think that we’re seeing the heat starting to turn up a little bit.”
“In my opinion, and I think in many people’s opinion, I think we’re all a little bit confused about how he got elected.”
—
Nicolette Baglio
election. The Capitol was attacked. Cawthorn: resign.”
Cawthorn’s not the only lawmaker under scrutiny from the PAC, which recently kicked off a $1 million nationwide billboard campaign highlighting Cawthorn and 10 others it claims “were the most irresponsible during the aftermath of the 2020 election.”
That includes Sen. Ted Cruz (R-TX), Sen. Josh Hawley (R-MO), House Minority Leader Kevin McCarthy (R-CA), Rep. Mo Brooks (R-AL), Rep. Matt Gaetz (R-FL), Rep. Louie Gohmert (R-TX), Rep. Marjorie Taylor Greene (R-GA), Rep. Jim Jordan (ROH) and Rep. Jodi Stefanick (R-MO).
The Republican Accountability Project is an offshoot of another advocacy group, Defending Democracy Together, which claims to be backed by “lifelong conservatives and Republicans — many of whom have served in Republican administrations and write for conservative publications.”
Cawthorn responded to the billboards with a statement issued Jan. 31 by spokesman Micah Bock:
“Rep. Cawthorn is disappointed to hear that local Democrats are once again funneling dark money, from outside sources, into N.C.-11. The Republican Accountability project is an affiliate of ‘Defending Democracy Together,’ which is a 501(c)(4) organization that spent $11.5 million dollars electing Joe Biden. The Republican Accountability Project is a front for the Democrat media

that we don’t have that in Madison Cawthorn right now.”
exploring and potentially supporting closer to the primary,” she said.
Today, WIN-NC counts more than 1,400 members — most of whom, like Baglio, are registered as unaffiliated voters. She estimates about 10 percent are Republicans, the rest Democrats. And just because “women” is in the name of the group doesn’t mean they don’t have plenty of men involved as well.
“In my opinion, and I think in many people’s opinion, I think we’re all a little bit confused about how he got elected, with a lot of the lies, and right now he’s kinda doubling down on that,” she said.
Another member of the group, Erin West, said that her experiences as a licensed clinical social worker who goes into some of the region’s poorest communities demonstrate the need for competent federal representation.
“Looking at his platform and what he was bringing forth to the community, I just didn’t really see much of a platform, just attacking the radical left,” said West. “[Cawthorn’s General Election opponent Col. Moe] Davis was so far from radical left that at times it was humorous, but then it became evident that [Cawthorn] was going to win.”
West, a Democrat, said she’s now considering changing her registration to unaffiliated, like Baglio, who expressed concern that North Carolina’s 11th Congressional District wasn’t drawn to be anything remotely resembling a competitive district.
“I will be honest and say that I don’t know that a democratic candidate is going to win the 11th,” she said. “I would love to see that, I think so many of us would, but I think the goal of the group is finding a candidate that represents the people’s needs in Western North Carolina. I feel collectively
That sentiment even goes so far as to leave Baglio open to supporting a Republican in a Primary Election contest against Cawthorn early in 2022.
“I think right now I know me myself personally, as well as a lot of members in the group are for finding a candidate Republican or Democrat, even a centrist that can beat Madison. So yes, that would be something that we’re going to look at
Baglio’s group took a big step less than a week ago, formally incorporating as a PAC so as to have an easier time raising and spending money in support of Cawthorn’s potential opponents. The group recently mailed thousands of postcards to Cawthorn’s Washington, D.C. office, and hopes one day to follow the efforts of the Republican Accountability Project with some local billboards of their own.







BY HOLLY KAYS STAFF WRITER
After nearly eight hours of discussion and testimony on Monday, Jan. 25, the first day of the quasi-judicial hearing that will determine the fate of a massive development proposed for Cashiers ended with developer Stephen Macauley asking the Cashiers Area Community Planning Council to make its decision based on an entirely different plan than the one he submitted last fall.
“We did what we thought was best, and I directed my team at every stage to follow that philosophical principle and to adhere to the (Cashiers) small area plan at every step. They did that,” he said. “However, over these last two, two-and-a-half months I’ve met with a lot of people who really had concerns about the density of the project and its impact that it would have. And I listened. We all listened.”
As a result, said Macauley, he was willing to reduce a 45-unit condo development in the southeast corner of the 55.5-acre property down to 15 units and to reduce the housing

density in the Hilltop Plaza area in the middle of the property by 40 percent. In total, the proposal would reduce the number of housing units from 726 to 581, of which 123 would be workforce housing.
“I hope that is accepted and shows that we’ve tried to be a good neighbor,” said Macauley.
However, the proposal — which was
announced verbally and not in writing — prompted vigorous objection from John Noor, the attorney representing several nearby property owners who oppose the project.
“My clients, as you might have imagined, have spent tremendous resources to review the plan as submitted, thousands and thousands of dollars in experts to do that, and now — not the day before, not a week before
— during the hearing the plan has changed,” he said. “I’m all for negotiation, but this is an undue prejudice to my clients. I won’t reflect on why it’s being done, but it obviously has substantial economic impacts on my clients’ ability to participate in this process.”
“I’m just a little shocked by the level of objection to an offer to reduce density when we have another meeting a month from now when his (Noor’s) witnesses might not even be reached at that meeting,” replied Craig Justus, the attorney representing Macauley Investments. “You can imagine the millions of dollars that have been spent on our side.”
However, Noor said, the project’s impact won’t necessarily go down in proportion with the reduction in density. Changing the way the project is arranged will mean changing the way landslide risk, stormwater impacts and other factors are calculated — it would “rewrite” every expert opinion given so far.
Noor also criticized Macauley’s decision to sit on the revised plans until the end of a long and grueling day of testimony. Gerald Green, the former planning director for Jackson County who was instrumental in authoring the Cashiers Small Area Plan, had just finished giving nearly two hours of testimony as a witness for the developer, which Noor said would have to be repeated in light of the new plan.
However, Justus replied, Green had — unbeknownst to anyone besides the developer — been giving his testimony based on the revised plans, which he’d received the night before.
In a follow-up interview, Noor criticized the “sheer unfairness of F








sitting on that information and not sharing it,” saying that the fact that Green had been privy to the revised plans prior to the hearing showed that the developer knew he was going to pursue the amended plan “days if not weeks” before the hearing occurred.
Justus did not reply to email requests for a follow-up interview.
“I don’t think that’s how you treat a community at all, by baiting and switching a project in the middle of an application process,” Noor said.
County Attorney Heather Baker said that midstream amendments like this are “not something we usually see” but that “there is case law to support” allowing such amendments without requiring the developer to withdraw the application and start over with a new one.
Ultimately, the Council decided to accept the amendment — pending a determination from county staff that it meets the technical requirements of the ordinance — and set a series of deadlines leading up to the next hearing day, scheduled for 9 a.m. Monday, Feb. 22.
The developer was required to submit its amended plan — complete with facts and figures that would allow it to serve as a “direct comparison” to the original — by Monday, Feb. 1, and that plan was indeed received just before 5 p.m. that day.
Senior Planner John Jeleniewski will complete a staff report on the new plan by Monday, Feb. 8. All additional affidavits and supporting documents for the hearing must be submitted by Monday, Feb 15.
In addition to hours of testimony on the latest version of the proposed development — the hearing will likely require multiple days to complete — the Feb. 22 meeting will feature a public hearing to clear up what planning staff say is an error in the county’s Unified Development Ordinance.
When the hearing opened Jan. 25, Noor began by presenting a motion to dismiss predicated upon what he said were two “fatal flaws” that meant the planning council did not have jurisdiction to approve the plan.
First off, he said, the UDO states that no development can have more than two points of access along any street or road, but the proposed development has five entrances on Monte Vista Road and five along N.C. 107. Secondly, the UDO states that no structures within the Cashiers Village Center District may exceed 5,000 square feet — but multiple buildings in the proposed development would cross that threshold.
“These are fatal flaws,” said Noor. “They have to be complied with under the code in order for the project to be approved. We would ask the board to dismiss the application because it lacks jurisdiction to approve a plan that would exceed portions of the UDO.”
Justus, however, called this motion a “hail Mary attempt” and said if it had been a valid objection Noor likely would have made it sometime in the more than two months that had elapsed since he took on the case. Noor did not present the motion until the morning of the hearing.
Regarding the entrance limit, Justus said
that the definition of “development” is key.
The UDO defines a development as “any one or more of the following” and then lists seven definitions, including “any activity requiring a building permit,” “any man-made change to improved or unimproved real estate,” “any land disturbing activity which … decreases the infiltration of precipitation to the soil,” among others.
“This is 50-plus acres of project that will have multiple buildings and in fact have multiple components, each of which under your ordinance would be considered a development,” Justus said.
Planning Director Michael Poston said that the argument regarding square footage was based on a pair of graphics carried over to the new UDO from the old planning ordinance that had an “incorrect citation.”
Here’s a look at the differences between planned housing in the original plan and the amended one submitted Feb. 1.
The original
• Phase 1: 211 apartments, 18 condos, 12 live-work units, 173 family residences
• Phase 2: 312 residential units
• Total: 726 units
The amended
• Phase 1: 191 apartments, 38 condos, 12 live-work units
• Phase 2: 149 single-family units
• Phase 3: 69 apartments, 122 singlefamily units
• Total: 581 units
The graphics state a maximum structure size of 5,000 square feet, but that limitation is not found anywhere in the actual text of the ordinance. The ordinance does give a 1,500square-foot limit on footprint size, but developers can exceed that limit if they secure a special use permit, as Macauley is attempting to do.
In the final minutes of the meeting, Poston returned to the podium to ask the council to schedule a public hearing clarifying that point.
“It certainly has been brought up as a point of contention and confusion, and we want to clear that up,” he said. “Certainly our operational understanding of how that standard is written and the contextual component of that plan would not cap the building at any specific size.”
Finalizing a text amendment to the planning ordinance is a lengthy process, requiring public hearings before the local planning council and county commissioners, with affirmative votes from each body and from the county planning board. That process can take anywhere from 45 to 90 days, depending on meeting schedules. The first step of the process, the public hearing, will take place at 9 a.m. Monday, Feb. 22, right before the permit hearing resumes.
For more information about the Macauley Investments project, including development plans and affidavits, visit www.planning.jacksonnc.org/cashiers-area-community-planning-council.





BY HOLLY KAYS STAFF WRITER
The number of Haywood County residents receiving a first dose of the Moderna COVID-19 vaccine jumped by 45 percent between Jan. 25 and Feb. 1, but vaccinations increased much more slowly over the same period in other mountain counties.
So far, 11.9 percent of Haywood County’s estimated population has received a first dose, as compared to 7.5 percent of Macon’s, 7.9 percent of Swain’s and 5.8 percent of Jackson’s, according to Feb. 1 numbers on the N.C. Department of Health and Human Services website and 2019 population estimates from the U.S. Census Bureau. Statewide, 7.6 percent of the population has received at least one vaccine dose.
Allison Richmond, public information officer for Haywood’s Emergency Management Team, said the county’s success is due to intense collaboration and a drivethru vaccination model that was first developed last spring for COVID-19 testing.
“It’s truly a community effort,” she said. “Coming together, putting all the egos aside and working on one common purpose is what we find we’re doing really well. We’re getting some requests for, ‘How do we do this
over here?’ It feels good to have brought all those resources together and to have been able to serve the community this way.”
Haywood County has been holding two vaccination clinics each week at the Smoky Mountain Event Center, formerly known as the fairgrounds, last week vaccinating 2,000 people at those clinics. The Haywood County Department of Health and Human Services received 500 first doses last week, not 2,000, but for the past couple weeks it’s been pooling its allotment with the Haywood Regional Medical Center to deploy all first doses at collaborative vaccination events.
The county expects to receive a smaller number of doses this week and for that reduced allotment to continue for the next few weeks as the state allocates resources to much larger vaccination events in the state’s urban centers. However, Haywood expects to have nearly all of its 75 and older age group vaccinated in the next few weeks and will then move on to people 65 and older.
Over in Jackson County, meanwhile, the number of first doses increased by just 151 between Jan. 25 and Feb. 1, mainly due to the fact that the county’s health department received only 100 doses last week while Harris Regional Hospital got

For information about vaccination opportunities in your county, visit the county health department’s website.
• Haywood County: www.haywoodcountync.gov/684/COVID-19-Information
• Jackson County: health.jacksonnc.org/covid19
• Swain County: www.swaincountync.gov/covidResponse.html
• Macon County: www.maconnc.org/covid-19.html
• Statewide stats: www.covid19.ncdhhs.gov/dashboard/vaccinations




•
zero. Previously, the entities had been receiving 500-700 first doses per week between them. As a result, Jackson County had to cancel its second planned drive-thru clinic last week, depleting all 100 first doses during a single event on Jan. 28.
Swain and Macon counties did slightly better last week, deploying first doses to 173 people and 354 people, respectively, inching up the percent of population vaccinated by just over 1 percent in each county.
However, the pace will likely pick up in Jackson over the next week. The health department will receive 300 first doses this week, and the hospital will get 100. The health department has been told to expect 200 doses per week for the next three weeks, and the hospital has been told it will hold steady at 100 over the same period. A team of six National Guardsmen has been assisting with the vaccination effort since Jan. 20 and will remain on duty until at least Feb. 26.
Blue Ridge Health is also offering COVID19 vaccinations in Jackson County, receiving 1,300 first doses last week and 1,400 last week for distribution at its clinics in Haywood, Jackson, Transylvania, Henderson, Polk and Rutherford counties. Of these, 100 went to Haywood and 400 to Jackson. WCU will soon be offering public clinics, with the University of North Carolina System on Jan. 29 announcing that 23 mobile cold-storage units were en route to all 15 research institutions in the UNC system. WCU is also one of three UNC schools chosen to offer vaccination clinics to the public, but no information is yet available on when those clinics might launch.
Up on the plateau, the HighlandsCashiers Plateau COVID-19 Vaccine Initiative has given out about 900 first doses in two vaccination events held at the Highlands Recreation Center Jan. 20 and Jan. 24. The initiative is driven by 18 different community partner organizations and 120 volunteers who aim to help the Macon and Jackson County health departments vaccinate rural communities in Cashiers and Highlands.
“We targeted our many elderly neighbors in Phase 2 who have difficulty in traveling to Franklin and Sylva for the vaccine,” said Robin Tindall, CEO of the Highlands Cashiers Health Fund, one of the initiative’s leaders. “The HCHF has been involved in organizing volunteers, and I just can’t say enough about how overwhelming it has been to experience this outpouring of our community coming together to offer their talents.”
Volunteers include physicians, pharmacists, medical professionals, town officials, technology experts and numerous other community members manning a daily call center
at 828.526.1310, as well as an appointment schedule and Facebook page. No doses have been received since Jan. 24, but the organization has a wait list of nearly 1,100 people, 864 of whom are over the age of 65. The plan is to offer weekly vaccination events for at least 12 weeks, as long as vaccines are available.
North Carolina surpassed the 1 million mark of COVID-19 vaccine doses administered across the state last Friday. This milestone capped a week when the state’s vaccine providers administered more than 99 percent of first doses, according to a state press release.
“I am so grateful to our vaccine partners across the state who continue working in innovative ways to make sure North Carolinians have a spot to take their shot. It is incumbent on
Haywood expects to have nearly all of its 75 and older age group vaccinated in the next few weeks and will then move on to people 65 and older.
all of us to use the limited supply of vaccine we have as quickly and equitably as possible, finding new ways to meet people where they are,” said N.C. Department of Health and Human Services Secretary Dr. Mandy K. Cohen.
The press release acknowledged that vaccine supply continues to be very low and that wait times are expected.
For the next three weeks, the state is guaranteeing baseline vaccine allocations to providers. Approximately 90,000 “baseline” doses are allocated based on population data from the State Center for Health Statistics to provide vaccine to all 100 counties.
The 55,000 “set-aside” doses of the state’s allocation are going to counties with higher numbers of people 65 and older with low income; counties with higher numbers of historically marginalized populations 65 and older and counties that received fewer doses per population in previous weeks.
Priority will also go to new vaccine providers who will provide greater access to rural and underserved communities and those who can provide vaccines to long-term care facilities not participating in the federal program. Community vaccination events geographically spread throughout the state will also take priority.
editor Jessi Stone contributed to this report.

Sarge’s Animal Rescue Foundation dedicated a memorial plaque to honor Gary Smith Dec. 17, at Sarge’s Adoption Center.
The plaque, initiated by Sarge’s board, is in the new permanent covered area in Sarge’s outdoor dog yard.
Smith, who passed away Aug. 25 in Waynesville, served on Sarge’s board for six years, with two terms as president and as Sarge’s treasurer. He and his wife, Sarah Jane League, produced Sarge’s Furry Friends Benefit Bash for seven years and fostered many dogs for Sarge’s at their home.
During the plaque dedication, remembrances were shared with League, an ardent Sarge’s supporter in her own right. Smith’s significant contributions to Sarge’s as an organization were recognized by staff and board members.
“Gary Smith was a kind and generous man — he gave so freely with his time and knowledge,” said Jed Lambert, Sarge’s board president. “He was a tremendous supporter of Sarge’s and was instrumental in the achievements of our organization. He will be missed, but because of all he gave to us and our community, he will never be forgotten.”
Sarge’s Animal Rescue Foundation is at 256 Industrial Park Dr., in Waynesville. For information, visit: www.sarges.org.

Sarge’s staff and board members met Dec. 17 to dedicate a memorial plaque to long-time Sarge’s supporter, Gary Smith. Pictured, from left, are Jed Lambert, Sarge’s board president; Sarah Jane League, Smith’s wife; and Steve Hewitt, Sarge’s treasurer. Carol Viau photo
Local animal welfare group Hope for Horses recently celebrated the opening of its new Waynesville executive office, and now they’re gearing up for a “mini-fundraiser” to help care for almost two dozen horses on three farms. Since 1999, the Buncombe County-based 501(c)(3) nonprofit has worked to find quality homes for abused, neglected and unwanted horses while also providing sanctuary for equines that cannot be adopted due to health, behavioral or other issues. Hope for Horses is also committed to helping responsible horse owners keep and care for their horses. The mini-fundraiser offers for purchase tee shirts, masks and tote bags, through Feb. 11. For more information on Hope for Horses, visit www.hopeforhorses.org or call 828-683-0160. To participate in the mini-fundraiser, visit www.bonfire.com/store/hope-for-horses.
Haywood Pathways Center’s third annual Empty Bowls dinner will look a little different this year thanks to COVID-19, but it’ll still feature the same great local soups and handmade bowls with all proceeds benefitting the same great cause. On Thursday, Feb. 25, Grace Church in the Mountains will host the drive-by affair from 4:30 to 7:30 p.m., and local band Arnold Hill will livestream a performance from 6 to 8 p.m., for guests to enjoy
at home with their soup. VIP tickets are $40, general admission $25, and $15 for soup flight only. Tickets may be purchased online at www.haywoodpathwayscenter.org or by calling the HPC office at 828.246.0332, or in person at the HPC office located at 179 Hemlock Street, in Waynesville.
Raffle tickets are $5 each, or five for $20. Local businesses and individuals are welcome to donate an item or service to be raffled at the event. Contact david@haywoodpathways.org to learn more about sponsorship opportunities.
The Pancake Day Team and staff at First United Methodist Church of Waynesville have wondered how to hold its beloved annual fundraiser during the COVID-19 pandemic. The decision was made to continue the tradition of serving pancakes to the community — just in a different way. Every year, for 64 years, hundreds of volunteers from FUMC-Waynesville cook and serve thousands of pancakes to thousands of people from the community on the last Tuesday in February.
This year, volunteers will be handing out Stay Home-Flip Safe Pancake Day Kits through a drivethrough in the church parking lot. Each packet will contain enough pancake mix to serve a family of four. Also included will be a bottle of syrup and a spatula for flipping the pancakes. Requests for packets or for more information, visit fumcpancakeday.com. Volunteers will be handing out Pancake Day packets in the church
tional capital needed to meet the goals of the NC Healing Communities Fund.
The gift will support the Fund providing critical resources for nonprofit organizations in North Carolina that have been impacted severely by COVID-19 through revenue loss and increased demand. The Fund’s focus will be to support nonprofits in marginalized communities that have been disproportionately affected by the virus and its economic impacts and have been underserved by other sources of financial assistance, specifically communities of lower wealth, communities of color, mostly rural communities and where English may not be the primary language.
As of the end of 2020, three long-standing Arc of Haywood board members stepped down after many years of service.
Gary Caldwell, Mayor of Waynesville, had been part of the board for over 30 years. He created and organized the Smoky Mountain 9-Ball Shootout, which will celebrate its 31st year in 2021. With his efforts over $300,000 was raised to support The Arc.
parking lot (Tate Street entrance) from 2 to 5 p.m. Sunday, Feb. 21; noon to 6 p.m. Monday, Feb. 22; and 3 to 6 p.m. Tuesday, Feb. 23, at 566 South Haywood St., Waynesville.
For more information, call 828.456.9475.
Elevated Mountain Distilling Company in Maggie Valley will host a special Valentine’s Day dinner event at 6 p.m. Sunday, Feb. 14. Fresh as Can Bee Catering will provide a four-course meal for $75 per couple. Bohemian Jean will entertain guests during the dinner with live music. The price also includes a special cocktail. Reservation must be made by Feb. 7. Call 828.545.0969 to make a reservation.
The board of directors of the North Carolina Community Foundation recently announced a gift of $3 million from the State Employees’ Credit Union Foundation for the North Carolina Healing Communities Fund, NCCF’s fund to benefit COVID19 pandemic response across the state.
The $3 million grant is comprised of two pieces — a $2 million general purpose grant which will help NCCF provide assistance to community nonprofits through its North Carolina Healing Communities Fund and a $1 million challenge grant which will help NCCF raise the addi-
Rita Phillips has also been a major force of The Arc along with her husband Ron, who passed away a few years ago. She has also served on the board, many committees and any other ways she could help over the years. She has more than 30 years working with The Arc.
The third member to step down is Jeff Schandevel, who became part of The Arc HC 18 years ago when he met and married another longterm board members, Rhonda, and became stepfather to her son who is part of the Arc community.
New to the Arc board of directors are Daniel Blagg, Haywood County Sherriff deputy, Realtor Mark Zaffrann, Lisa Cook, Haywood County Schools Exceptional Children’s Teacher Lisa Cook and Audrey Best, teacher at Clyde First Baptist Preschool.
The Fund for Haywood County, an affiliate of The Community Foundation of Western North Carolina (CFWNC), is accepting applications for its spring grant cycle from nonprofits serving Haywood County.
Grants up to $3,500 will be awarded for projects that exhibit the greatest community benefit. The deadline to apply is Feb. 5. The online application is available at cfwnc.org/Grantseekers/GrantDirectory.
The 2021 cycle of the Mib and Phil Medford Endowment Fund is also open for applications. Medford Fund grants are for beautification, streetscape improvements and other public amenities within the city limits of the Town of Waynesville. To apply, contact Senior Program Officer Tara Scholtz at scholtz@cfwnc.org or 828.367.9913 to discuss your proposal.
Learn more at www.cfwnc.org.
With so much division in our country, and some folks even losing faith in democratic government, I would like to offer a proposal concerning Medicare. I do this in the hope that such a proposal if implemented could help restore some faith in government.
I am calling upon the Biden Administration to lower the Medicare age of eligibility to 55.
Most of us either rely on Medicare for our own health care, having reached 65, or have a dear relation or friend who does. After our armed forces, Medicare may be the most popular part of the U.S. federal government. Since its adoption in 1966 it has kept millions of our senior citizens healthy and out of poverty once they qualify at age 65.
But by age 55, many people have been working for 30 years or more. Many are tired, and are beginning to suffer from various chronic illnesses. Unfortunately many are underinsured, uninsured or paying very high premiums. Some are small business owners who have tried to keep their employees
To the Editor:
In the aftermath of recent events in our nation’s Capitol, we are still reeling in shock, disbelief and consternation at how best to pick up the pieces and move on. We hope that leadership will emerge to restore the ship of state to a democratic, compassionate and confidence-building course.
At the same time, however, we must not lose sight of an even-greater catastrophe looming on the horizon, bearing down on us with a prospect that could make storming the Capitol look like the proverbial “tempest in a teapot.” The terrorist assault on the Capitol posed a threat to our democracy. Humankind’s assault on the planet poses a threat to our survival. The Jan. 6 attackers have been characterized as a “gang of thugs.” Those who threaten the Earth’s future are “nice people” like you and me who cannot or will not adopt the radical changes in our economic system and comfortable lifestyle essential to turning around our Earthship now headed toward disaster.
Between 1990 and 2015 the richest 1 percent of humanity accounted for more damage to the environment than the entire bottom 50 percent. This 1 percent includes any with annual incomes over $109,000. The richest 10 percent, those making over $38,000, account for half of total emissions. Those of us with “decent” incomes — likely most readers of this paper — live in places allowing us to downplay or ignore the damaging effects of our fossil fuel dependency, while the lives of folks residing in Bangladesh, Vanuatu, “Cancer Alley” and other minority and poverty enclaves, bear the brunt of it. Our grandchildren are rightly up in arms as the viability of their future is threatened.
In the midst of the trauma and violence on Capitol Hill — and the underlying dis-ease
insured (I was one of these employers).
We all know of folks “hanging on” until they reach 65, foregoing medical care, afraid to change jobs or start a business. Lowering the Medicare eligibility age would be a triumph of decent and potentially bipartisan politics. It could renew faith in the system for many who feel angry, left out of the American Dream, unappreciated and even betrayed.

How could this be paid for? By raising the $133,000 ceiling of the Medicare payroll tax, as has been proposed for years now. Today, someone earning $500,000 a year pays the same total amount of Medicare tax as someone earning $133,000. By raising the ceiling — to $250,000 or whatever actuarial figure is appropriate — the increases in Medicare expenses will
and alienation that has fomented it — can we re-affirm our commitment to implementing human rights and equality of opportunity for all? As the COVID-19 pandemic causes us to invent new ways of communicating with and caring for one another, can we also find the will to sacrifice some of our comfort and convenience, and to divert resources from feeding our greed to nurturing the common good? Will we draw on our capacity for creativity and invention to replace carbon with alternatives, to put people before profits, to find adventure and fulfillment in a simpler life in place of the exotic and luxurious? Can we adopt a system that guarantees liberty and justice (and healthcare and education and security and a livelihood with living wage and the chance to achieve one’s potential) FOR ALL?
We went to the moon a half-century ago. We have now set our sights on Mars. Is not climate justice a worthy — yes, essential — goal as well? As Pope Francis put it recently, “The Earth must be taken care of, cultivated, protected; we cannot continue to squeeze it like an orange.” To do so would only extract the juice of life, leaving only the pulp of debris — as did the Trump marauders.
Doug Wingeier Asheville
To the Editor:
I always enjoy the illuminating letters from Carol Adams. Her most recent (last week’s Smoky Mountain News, www.smokymountainnews.com/opinion/item/30705) was especially spirit-lifting. I was relieved to learn that the thugs who attacked the Capitol on Jan. 6 wearing MAGA hats and waving Trump flags were not Trump supporters (as commonly believed). Thankfully too, the attack on
be paid for. When upper income people complain about their higher taxes, they should be reminded that they too would be eligible for Medicare at age 55 and be freed from their insurance premiums. Private supplements should of course remain available for those who wish to add them to their Medicare insurance.
Businesses will also pay more as they match the Medicare contribution of their employees — recently 1.45 percent of payroll. This will be greatly eased by being released from paying premiums for middle-aged workers who often have the most expensive medical bills.
The anger and division in our country can perhaps be partly explained by the burden of health care insecurity and the enormous related economic challenges encountered by many families. Bankruptcies, for example, are a well-known and unacceptable feature of our nation’s failure to address these issues effectively. The 55-65 years of age cohort is certainly affected by this.
If you find this proposal of interest, contact congressmen Madison Cawthorn, Patrick McHenry and others. They need to hear from you!
(Stephen Wall, MD, FAAP, is a retired pediatrician who lives in Waynesville.)
the Capitol Police, the looting, trashing and destruction was not committed by Trump supporters either because (as Adams enlightens us) “that behavior is not in their collective makeup.”
No, we didn’t actually see what we thought we saw being broadcast around the world. The chaos, the ravaging of the House and Senate chambers, the violence, the devastation and havoc was more likely the work of those who have “a well-documented track record of inciting violence.” That would be (according to Adams) “media personalities, leftists, never-Trumpers and Trump-hating politicians,” and, oh yes, “the courts.”
Absent a shred of confirmation, not one iota of proof, not a scintilla of evidence, Adams is sure Trump is “1000 percent correct” that the 2020 election was a fraud.
Ms. Adams, this may come as a shock to you and to the Republican Party but — boys and girls — truth matters.
David L. Snell Franklin
To the Editor:
Humanity has a universal propensity for lies and distortions, and Trump-supporting extremists ruled by reality-free ideas are front and center in the public view, as events in D.C. show. But the truth is that we are all prone to fantastical intellectual views that confirm our entrenched internal biases, ideas that identify the bad and evil guys over there and the good guys that we hang out with.
Sixty years ago, I often witnessed the denigration and deliberate demeaning of Black people, and my young eyes did not miss the sadistic pleasure that ordinary white folks were deriving from this barbaric activity. No one today with access to the internet or a television believes society has eliminated all such
behavior and the attitudes that support it. Mostly racism has gone underground, out of view, waiting to rear its ugly head when allowed. In these and many other societal structures that are destructive and non-nonsensical, substantial lies are involved, like claims of racial or cultural superiority. The same kind of deceit is involved in no end of other obscene societal events, like the giving of tax breaks a few years ago to the wealthy while masses of poor folks cannot both pay the rent and feed their children.
On Jan. 6, the same kind of detachment from obvious reality was on prominent display by masses of Trump followers, including our local Rep. Madison Cawthorn, who actively endorsed and repeated the brain-dead, dangerous claims of election stealing and promptings to riot by an obviously mentally deranged man. There is only one way out of the morass of indecency and delusion that has taken over the Trumpian wing of the Republican Party, and that lies in emphatic attention to the twin demands of truth and suffering. The first is obvious; no debate or deliberative process can yield useful and lasting benefit if it fails to start and proceed with ideas that accurately reflect reality. The second provides the point of why we deliberate at all. If our efforts are not to address real and common suffering, then the debate is just a bunch of hot air being expelled to bolster the coffers and reputations of ego-driven buffoons that do not actually represent the electorate, and we will continue to provide the good life for a thinner and increasingly isolated wealth class. The truth is that the wealthy do not need our help, but poor folks clearly do. The middle class is getting squeezed, and that has to stop. Mentally and emotionally unbalanced folks often end up in jail rather than in treatment, which is a pox on the individual and a burden on everyone else. Minority citizens are the ones that need to worry about racial profiling, excessive incarceration and suspicious police, not white people. Corporations do not
the Editor:
For weeks leading into the insurrection and ransacking of our Capitol on Jan. 6, Madison Cawthorn’s words and actions fomented a mob of traitors by supporting our former president’s lies. He did so instead of representing us in North Carolina’s 11th District.
In the aftermath of the failed coup, Cawthorn has tried to distance himself from criticism, outrage and questions. Through deliberate equivocations, deflection and attempts to redirect the national focus away from calls for accountability from both the insurrectionists and members of Congress who encouraged them, Madison has shown a profound dereliction of duty and moral authority, mirroring the failed legacy of our last president’s. The past few weeks have shown that Cawthorn’s position as our representative threatens to continue an atmosphere of dishonesty and division. He is the wrong man for both this moment in time and for the people of Western North Carolina.
Without taking ownership for his missteps and mistruths, Cawthorn continues to dig himself deeper. Attempting to distract from his actions during the Jan. 6 riot, a Cawthorn spokesman recently condemned “all violence” and stated NC-11 Democrats had not, insinuating their support of violence and lawlessness. WNC Democrats did publicly condemn the riots, but he and his team seem to assume we and others nationwide wouldn’t take the time to look into the accusations. These Democrats have since received threatening phone calls.
In the same article, they lied about our Buncombe neighbors, stating in no uncertain terms that Asheville’s Black Lives Matter protests had “burned businesses,” “looted” and attacked police. None of this happened here, and it’s an insult to all of us who he is supposed to represent.
Many of us have friends or relatives from whom we can inquire about the truth of those days this past summer. From what I’ve heard in my circles, the protests in Asheville were overwhelmingly peaceful — as were 93% of the protests nationwide. I’ve also heard and read about how law enforcement at the protest initially took a knee to show solidarity with the activists. Other protests I was lucky enough to join were held in Sylva, Maggie Valley, Waynesville and beyond, and these were all peaceful, positive and without more than some arguing between activists and counter-protestors.
Madison Cawthorn either doesn’t know this or doesn’t think much of who he was
need protection from nature, but rivers and the air we breathe needs to be protected from them.
And there are many other inequities that deserve our best efforts to eliminate them. We are wasting our time and limited resources propping up that which is already substantial and secure.
At the dawn of the Biden/Harris era, I hope that we can continue a national conver-
expected to represent. Perhaps he was out of town, or too focused on Raleigh and the opinion of the other six N.C. congressmen who also voted against our country and constitution on Jan. 6. Even as the media focused on him more and more, he’s failed to focus on WNC. Perhaps it’s because he doesn’t live among our mountain communities, alongside regular people like me and you. Instead of with us — his constituents — Cawthorn has put his faith in false claims and the liars who’ve said them.
Immediately after the election, he was a sore winner and blamed anyone who didn’t vote for him on “cancel culture.” To this day he has owned up to nothing and repeatedly shifts responsibility to the media. He’s said and done all of this while expecting us to trust he’ll represent us fairly.
As his constituents, it’s our responsibility not to forget these lies, nor those Cawthorn continues to spread, and to assume the threatening phone calls to those who disagree with him and the actions on Jan. 6 were supported and inspired by his words. Examples of this are numerous, like his suggestion to “lightly threaten” other members of Congress at an event in late December. He went on to encourage the crowd to say he and the mob of attendees (and anyone who watched from elsewhere) would “come for them.”
The awful occurrence on Jan. 6, much like 9/11 and Pearl Harbor, will not be forgotten — and neither should Cawthorn’s hand in it. He, as WNC’s representative in D.C. and obvious partner in the crimes of President Trump, Rudy Guiliani and others, will be forever connected to the embarrassing incitement of the mob and their ridiculous actions that day.
If Cawthorn will lie about those he was elected to represent — including protestors who stood for Black Lives all across his district — it shouldn’t surprise us that he (and the other six of N.C.’s “Seditious Seven”) voted against the will of the people in an attempt to overturn the valid presidential election results — even after the events on Jan. 6. He seems to assume we, the people of his district, won’t bat an eye at the lies and distractions he’s said during recent interviews. This behavior is childish and has no place from our elected leadership where it can clearly cause so much harm. We shouldn’t forget any of this.
Cawthorn clearly has no concern for the mandate of his constituents, and he needs to go before embarrassing himself, and all of us, any further.
Jonathan Wood Cruso
sation and debate on the basis of a respect for the truth, and the needs of those among us with less than a fair shot of life. Is that not why we created a country and maintain a government in the first place? And if it is not, then why bother entertaining democratic ideals at all? What would be the point of all this noisy effort and astronomical expense?
Rick Wirth Bryson City






Pink Beds release debut rock album
BY GARRET K. WOODWARD STAFF W RITER
What started out as a casual jam to entertain a keg party has morphed itself into one of the most intriguing new musical acts in Western North Carolina.
“By August 2019, my old band had come to an end. Some friends of mine from college were looking for someone to play their Halloween bash, and I said ‘yes,’ all while forgetting I didn’t have a band anymore,” Aaron Aiken laughed. “Nobody wanted to travel to the gig and we weren’t getting paid, so I just called up some friends who play around the area. When
the party ended, we talked after and decided ‘let’s not make this our last gig.’”
Lead singer of Pink Beds, Aiken, a Brevard native, now fronts an Asheville group that stands at the intersection of indie rock, psychedelic folk and cerebral pop. It’s a seamless blend, more so a vibrant flow, that harkens back to the sounds of early 2000s indie icons The Strokes and Keane, with a thick thread leading to the melodic camps of Tame Impala and Snow Patrol.
With its debut album, “All I Have,” dropping last month, Pink Beds emerged from the Halloween 2019 gathering ready and roaring to perform live, only to spend most of the 2020 pandemic hunkered down in Aiken’s West Asheville home. The quartet would (and continues to) huddle in the basement, working out new tunes or simply jamming out until someone had to go and not be late to their day job.
Now the record is out and being happily consumed by Pink Beds’ growing fan base. Recently, there was an album release party in the basement. Only a handful of close friends and family were (safely) allowed in to bear witness to what Pink Beds has been concocting during the shutdown, each attendee walking away in sheer awe of the presence and tone of this captivating ensemble eager to emerge from the underground.
Smoky Mountain News: It must have been a little deflating to have this seed planted in your head in late 2019 of starting this new
We were a brand new band [in early 2020], essentially playing a bunch of songs that I had written for other bands that never came to fruition. So, in this moment, we’re finding out what we want to sound like, because these are old songs that I have. I’m showing them to these guys and they’re becoming a whole other beast.
Since we couldn’t play shows because of COVID, it was kind of nice because instead of trying to rebirth songs, I had the freedom and the free time to write a whole new album for this band.
Months and months of me in the house — I record something and send it to the boys. Then, they’d send something back or we’d meet up, show each other what we came up with and restructure it. We [had time to] focus only on an album.
SMN: How much did it mean for you to have that creative outlet during the shutdown?
AA: Oh, man. If I didn’t have that, I don’t know what I would’ve done. This one [creative outlet] definitely took up about 80 percent of my time.
SMN: I was very impressed from what I saw at the album release party. The sound is very cerebral and intricate, but also very danceable. Was that by design or did the band evolve into that sound?
“I
don’t think I’d ever write a song for anyone else but me. I start a song because I feel like it’s something I want to see come to fruition or I had to get off my chest or it’s a story I needed to tell.”
— Aaron Aiken
Pink Beds debut album, “All I Have,” is now available for purchase and streaming on all digital music platforms. For more information on Pink Beds and an upcoming show schedule, click on www.pinkbedsmusic.com.
band, where you bust out of the gate and play a couple of gigs, only to come to a complete halt with the shutdown.
Aaron Aiken: Exactly. We had some festivals in June [2020] that we were super excited for and obviously none of them happened. But, I think there were a lot of positives out of the negatives.
AA: I think we’re still evolving the sound. I mean, it’s still early because we’re getting into a practice regiment, so when things open back up, we’re ready. It’s a soundscape that I’ve had in mind since we started the album, it’s just figuring out how to accomplish some of it.
SMN: When I heard Pink Beds, I immediately started to think of those great indie rock acts like The Strokes or Tame Impala — this very danceable music, where there’s all these levels to the sound, these melodic rabbit holes.
AA: Yeah, totally. You definitely want energy behind the songs live. If you’re playing with emotion, you have your body movement, which is your beat. You want it to be danceable and you want it to be slow. You can instantly hear that in the music.
And I’m a huge vocal melody guy. That’s probably the most important thing for me in music. You mentioned The Strokes, so [their lead singer] Julian Casablancas does that really well. Having layers is super [important] to us. If it’s too surface level, people see right through it.
I don’t think I’d ever write a song for anyone else but me. I start a song because I feel like it’s something I want to see come to fruition or I had to get off my chest or it’s a story I needed to tell. So, coming from something like that always gives it a little more purpose.
The most rewarding feeling might be seeing a song come together. You kind of go into this dreamlike state and you kind of know where it’s going, but then there’s the whole journey of starting it and, “Oh, didn’t see that coming, let’s run with this” — it’s this fun puzzle that you’re putting together and putting out into the world.

BY GARRET K. WOODWARD
Western North Carolina has lost a truly kind and beautiful soul. Erica Waldrop passed away in a tragic car accident last week. She was a friend to many in Sylva and greater Jackson County. A shoulder to lean on. A smile to brighten your day. She was also a friend of mine, too. A good one.
I first crossed paths with Erica about eight or so years ago through her brother, Brad. I had just moved to this area from Upstate New York to start work at The Smoky Mountain News. Not knowing a single person ‘round these parts, I did what I always did in those situations, which was track down local live music and try to make some new friends.
Now the owner of Ward Plumbing & Heating in downtown Sylva, Brad (at the time) was living and working in Atlanta. A Jackson County native, his ATL indie rock band would roll through Sylva and Waynesville, playing shows at breweries and restaurants. Brad and I became immediate friends, which then parlayed itself into becoming welcomed and loved by his immediate family, the Waldrops of Webster.
You had Brad’s parents, Dave and Edna, two salt-of-the-earth folks. If you’ve ever read our “Letters to the Editor” section of the newspaper, you know Dave’s submissions well: always intelligent and thought-provoking, always aiming to build a bridge of understanding and compassion amid times of social and cultural division.
And Edna? One of those deeply kind and gentle souls that renews your faith in the good of humanity, the endless possibilities we have on this planet just so long as we remain steadfast and decent to each other. She’s a matriarch of the truest sense, who carries herself and her actions quietly, but you damn well better realize the respect and wisdom that comes along in doing so.
There was always a seat at the Waldrops kitchen table during the holidays, many of
which I was graciously invited to partake in, seeing as I was usually a “Damn Yankee” orphan during Thanksgiving and Christmas. And, like clockwork, I was right there sitting at dinner alongside Erica, her signature hearty laughter and ear-to-ear smile beaming in the midst of conversation, usually in the presence of tall tales retold for the thousandth time by Dave or Brad.
Erica was many things to many people. Of note, she was a social justice warrior who stood proudly at any and all community marches, most recently the Black Lives Matter and Confederate statue gatherings in front of the Sylva fountain. She was also a helping hand and the life of the party. If you were passionate not only about life, but what you wanted out of it, she was right there to amplify those aspirations into the universe. She never met a stranger, and was always connecting the dots of people, places and things within any social setting.
But, most importantly, she was the mother to Ella, a spitting image of her (red hair and freckles, that ear-to-ear beaming smile), whose fierce independence and stoic nature (even as a teenager right now) is a chip off the ole block. Our sincerest sympathies to you, Ella. All of us, whether related by blood or friendship, will always have your back and champion your dreams.
Anytime I would run into Erica at a concert, bonfire or happenstance gathering, there was always a kind word of mutual appreciation shared between each other. She was a firecracker, a kindred spirit, truth be told, one who I think was somewhat misunderstood by others, though I think that’s why we got along so well: we had the same wild hairs.
What’s surreal was the candlelight vigil for Erica held late Sunday afternoon at the Sylva fountain. The same spot where she would protest for the rights of others mere months ago, the hope within her heart and soul of finding common ground between others for the greater good. The vigil was filled with an array of familiar and beloved faces, all of which I hadn’t seen since before the pandemic and shutdown.

I love and miss every single one of those familiar faces, sad eyes peering out from just above their masks, words of support and encouragement muttered under the breath of grief and sorrow. This is not how we wanted to be reunited with each other, and this isn’t how we figured things would go in the grand scheme.
But, this is life, come hell or high water. Though we know we’re never guaranteed tomorrow, we wake up in gratitude to be able to walk outside and try to make the world a better place, whether it be around the corner or around the globe. We hold steady, and we remain there for one another. We push on to the best of our abilities, and
we hold each other up — just as Erica would (and did) for so many of those familiar and beloved faces, sad eyes peering out from just above their masks.
I’ll miss you, Erica. We all will.
Erica Waldrop is survived by her daughter, Ella; her parents, Dave and Edna; her brother, Brad, and his wife, Kendall, as well as their daughter, Magnolia Pearle. She’s also survived by all who knew and loved her — moments and interactions that are now forever chiseled on the walls of our memory. To you who read this, make sure you tell those you love how much they mean to you. Embrace love. Radiate compassion. Promote empathy.
Life is beautiful, grasp for it, y’all.

When asked to name a major film that they like featuring a person with a disability, the subjects of the documentary film, “Code of the Freaks,” respond with “No, I can’t name any” and “Yeah, that’s a pretty short list.” Playing a character with a disability, no matter how unrealistic or demeaning the portrayal, may be the quickest way for an actor to win an Oscar.
“Code of the Freaks,” directed and produced by Salome Chansnoff, imagines a cinematic landscape that takes people with disabilities seriously. Bardo Arts Center presents an opportunity to watch this dynamic documentary on-demand from Feb. 21-24, watching details below.
From 1932’s “Freaks” to “Forrest Gump,” Hollywood has propagated persistent tropes about characters with disabilities. But now, people with disabilities who have historically been excluded from the industry are increasingly being seen and heard by mainstream audiences. “Code of the Freaks” features their voices in interviews with activists, educators, as well as those who work in front of and behind the camera.
“Movies have the power to shape the beliefs and behaviors of non-disabled people toward people with disabilities, and of disabled people toward themselves,” says Chasnoff, “We wanted to make a movie that would give viewers tools to better understand what they’re watching. We called upon disabled artists, writers, scholars and activists to confront the dilemma of the disabled body onscreen, and present real-life alternatives to the stock characters and tired plots that exoticize, idealize, ridicule or demonize disabled characters.”
The documentary is available to watch on-demand from Feb. 21-24. Once you begin watching the documentary, you have 24 hours to finish. Watch on a browser or through the EventiveTV App. Learn more and pre-order your free ticket at arts.wcu.edu/codeofthefreaks.
This event is made possible through the Southern Circuit Tour of Independent Filmmakers, a South Arts program. Since its inception in 1975, Southern Circuit has brought some of the best independent filmmakers and their films from around the country to communities throughout the South. The program is supported by the National Endowment for the Arts. www.wcu.edu.
The “Valentine Train: Wine & Rail Pairing Experience” will run from 10:30 a.m. to 3 p.m. Saturday, Feb. 13, departing from the Great Smoky Mountains Railroad depot in Bryson City.
Specialty train experience riding in a full-service, all-adult first class car with a private attendant and plush, well-appointed dining seating. A narrator will be onboard to discuss each pairing of four wines with a meal that includes an exclusive sampling of local cheeses, a surf-n-turf meal prepared fresh, and a chef-inspired dessert perfect for the season.
All passengers also receive souvenir stemless wine glasses. Age 21 and over only. For more information and ticket prices, call 800.872.4681 or click on www.gsmr.com.
• Balsam Falls Brewing (Sylva) will host an open mic from 8 to 10 p.m. every Thursday. Free and open to the public. www.balsamfallsbrewing.com.
• Elevated Mountain Distilling Company will host semi-regular live music on the weekends. Free and open to the public. www.elevatedmountain.com.
• Frog Level Brewing (Waynesville) will host semi-regular live music on the weekends. Free and open to the public. www.froglevelbrewing.com.
• Lazy Hiker Brewing (Franklin) will host Natti Love Joys (roots/soul) Feb. 6 and Scott James Stambaugh Feb. 13. All shows begin at 7 p.m. unless otherwise noted. www.lazyhikerbrewing.com.
• Lazy Hiker Brewing (Sylva) will host Natti Love Joys (roots/soul) Feb. 5 and Bridget Gossett Feb. 12. All shows begin at 7 p.m.

Listen for new episodes of “Down the Road” on the Blue Ridge Music Trails of North Carolina, a series highlighting traditional and bluegrass music and stories, beginning this week on WNCW-FM at Isothermal Community College in Spindale.
The series is created by the Blue Ridge Music Trails of North Carolina, an initiative of the Blue Ridge National Heritage Area and the North Carolina Arts Council, in partnership with WNCW-FM.
The segments air on WNCW-FM (88.7) Mountain Mornings on Tuesdays at the end of “Morning Edition” alternating with “Southern Songs and Stories.” “Down the Road” is also repurposed as online content by the partners.
County legend Byard Ray, the influence of the Farmers Federation on music in Western North Carolina and a look at the banjo builders in the region. Boosinger’s long history as a performer of traditional and bluegrass music as well as her musicologist background and knowledge of the region provide rich context for the segments.
“We are excited to offer this new set of ‘Down the Road’ episodes to convey the rich music legacy of Western North Carolina, from our heritage artists to rising traditional music performers of today,” said Angie Chandler, executive director of the Blue Ridge National Heritage Area.
unless otherwise noted. www.lazyhikerbrewing.com.
• Nantahala Brewing (Sylva) will host semiregular live music on the weekends. Free and open to the public. www.nantahalabrewing.com.
• The Haywood County Arts Council’s “Winter Member’s Show” will be held Feb. 5-27 in the Gallery & Gifts showroom at the HCAC in downtown Waynesville. Original work for 24 local artisans. Free and open to the public. www.haywoodarts.org.
• The Bethel Christian Academy will be hosting the “Papertown Spring Market” fundraiser on March 13. There will be booths for local vendors to set up and sell their products: boutique clothing, home decor, jewelry, and more. 828.734.9733.
• There will be a free wine tasting from 6 to 8 p.m. every Thursday and 2 to 5 p.m every Saturday at The Wine Bar & Cellar in Sylva. 828.631.3075.
“At WNCW, we love our mountain music and Appalachian cultural traditions, so it is a natural fit to air ‘Down the Road’ on the Blue Ridge Music Trails on FM as well as via podcast,” stated Joe Kendrick, WNCW’s director of programming and operations. “It is a great pleasure to join in with their team and work together to preserve our region’s music and strengthen its future.”
The partnership includes the production, broadcast and online distribution of the new series of radio segments and podcasts featuring Laura Boosinger, celebrated musician, folklorist and storyteller, as host. The segments highlight bluegrass and old-time music stories, performers and musical traditions across the 29 mountain and foothills counties included in the Blue Ridge Music Trails of North Carolina footprint.
Produced by WNCW-FM, the short segments cover such subjects as a story about the journey of a fiddle once owned by Madison
The title of the segment is based on the tune “Down the Road” from the Doc Watson Family.
The Blue Ridge Music Trails of North Carolina is a project of the Blue Ridge National Heritage Area in partnership with the North Carolina Arts Council. For more information, visit www.blueridgemusicnc.com.
WNCW-FM is an independent public broadcast service of Isothermal Community College and broadcasts at 88.7FM with WNCW 88.7 FM is a public radio station owned and operated by Isothermal Community College.
The station, which celebrated its 30th anniversary last year, is a nationally known leader in the Americana and Triple A, or adult album alternative, formats. WNCW 88.7’s main signal can be heard in parts of five states.
The station also has translators in Boone, Charlotte and Greenville, South Carolina. In addition, WNCW broadcasts over the 90.7 frequency on WSIF FM in Wilkesboro. For more information, visit: www.wncw.org.
Many of us who read novels find ourselves in awe of authors who create a landscape and a place so well that we can see the fields and forests, hear the birds, and feel the sunshine and rain on our faces.
In his short story “Big Two-Hearted River,” and in so many of his other stories and novels, Ernest Hemingway pays close attention to the weather, the terrain, and the plants and wildlife, in this case focusing on Upper Michigan. As I have mentioned in earlier reviews, Pat Conroy had the talent to make readers taste and smell the Low Country marshes of South Carolina, and James Lee Burke in his Dave Robicheaux novels does the same for Louisiana.

In The Last Entry (Working Title Farm, 2019, 287 pages), novelist Jim Hamilton follows their example by bringing alive the flora, fauna, scenery and weather of the mountains of Western North Carolina. Hamilton’s story focuses on Tucker Trivette, an Appalachian boy whose alcoholic father either ignores or thrashes him and whose crippled mother constantly berates him for his failures. But his grandfather, who knows the mountains better than anyone else Tucker will meet, loves the boy, imparts wisdom to him about virtues and living, and in particular teaches him woodcraft, especially where to find ginseng, how to harvest it without damaging its value at market, and ways to help the plant thrive for the future.
After his grandfather’s death and his graduation from high school, Tucker follows in the footsteps of the old man and joins the Navy. While on shore leave in Hong Kong, he meets Wei, the daughter of a Chinese entrepreneur specializing in the importation of ginseng. Tucker promises her he can deliver her an enormous supply of this much sought after medicinal herb and returns home after leaving the Navy with expectations of making some good money.
But home is not what it once was. The ginseng he planted before leaving is gone, some of it possibly taken by poachers, some dead or withered from his lack of knowledge about the soil. His parents’ home has
burned to the ground, leaving his father dying in a hospital, his mother dead, and his brother missing and presumed dead by others in town. The money he had deposited in the local bank during his time in the Navy is

gone, stolen by a relative and his parents.
Meanwhile, he also has a series of runins with “Rat,” an old school enemy, and his band of druggie thugs. Another schoolmate, Allie, has also returned to the mountains to live, and she and Tucker continue their verbal sparring, clearly attracted to each other but unable to resist sniping and hard feelings.
To describe the rest of the story — how Tucker earns enough to eke out a rough living, his fights with Rat, the fate of his brother, and the notebook belonging to his grandfather with its secret codes, possibly about where to find ginseng — would ruin the suspense of this fine tale for readers.
As stated earlier, Hamilton has a gift for describing our mountains, especially its plant life. Here, for example, is a scene early in The Last Entry:
“Paw Paw had showed the boys how to find bloodroot and ginseng’s other companion herbs. ‘Bloodroot and ‘seng are like two peas in a pod,’ he’d said. So was poison ivy, it seemed.
Everywhere he dug ‘seng, Tucker awoke the next morning with itchy fingers and forearms — the sap from unseen tendrils of the toxic vine blistering his skin. A little jewelweed rubbed between the joints could take the itch away and numbed the welts from the stinging nettle, too. The woods were an endless apothecary, and Paw Paw knew all of its healing secrets.”
Another fascinating feature of the novel was the theft and violence ginseng brings, even today. Readers of The Last Entry may disbelieve poachers and thieves in the 21st century would so value this herb as to risk arrest or even being shot, yet as recently as last year an article in National Geographic, “Demand for ginseng is creating a ‘Wild West’ in Appalachia” reports that growers have armed themselves to protect their crops, and the Forest Service has cracked down on those stealing ginseng from our national forests.
Just as in Hamilton’s novel, the Chinese desire for this herb is driving this phenomenon. In his “Afterword” to the The Last Entry, Henderson points out that ginseng is an endangered species “due to overharvesting in the wild for its export to Asia, where it is valued for traditional, wide-ranging medicinal applications.” He goes on to encourage readers to “plant some seed to keep this special plant and its traditions going forward,” and offers some technical resources to help them do so.
Finally, The Last Entry offers readers a view into the lives of the ordinary people whose ancestors settled these mountains. Like them, many of these descendants have retained a spirit of independence, the value of hard work, and the ability to rise above harsh circumstances. They love and trust kinfolks and friends, and often offer help to them when trouble comes knocking at the door.
In this time of pandemic and divisiveness, Hamilton’s characters and their stories remind us of the many good people living among us in this world.
(Jeff Minick reviews books and has written four of his own: two novels, Amanda Bell and Dust On Their Wings, and two works of nonfiction, Learning As I Go and Movies Make the Man minick0301@gmail.com)



The annual NC State Poetry Contest is a free literary competition open to all North Carolina residents, including out-of-state and international students who are enrolled in North Carolina universities. It remains one of the largest free-to-enter poetry contests in the South. This year’s guest judge is award-winning poet Kayleb Rae Candrilli and features a grand prize of $500. No emailed entries are accepted. Please mail entries to: N.C. State Poetry Contest, Department of English, North Carolina State University, Campus Box 8105, Raleigh, NC 27695-8105. The postmark deadline is March 1, 2021. Due to volume, we cannot contact each contestant or return your poems afterward. Winners and honorable mentions will be contacted directly. There will not be a public ceremony this year due to the COVID-19 pandemic. The results will be posted on our website. For more information, visit go.ncsu.edu/poetrycontest.







BY HOLLY KAYS STAFF WRITER
The sky shone an unbroken blue and afternoon sunshine cast sparkles on the lazy Pigeon River as a group of volunteers gathered in the mud-caked parking lot of Rivers Edge Park in Clyde Jan. 29.
“This is a marathon, not a sprint,” said Adam Griffith, director of the Revitalization of Traditional Cherokee Artisan Resources Program at the Cherokee Preservation Foundation, holding a piece of dried river cane in his hand.
Griffith was referring to the slow growing pace of river cane, which the group was there to help plant on the banks of the Pigeon River,

but the same could be said for Rivers Edge Park as a whole.
Located along Thickety Road not far from downtown Clyde, the park sits in a historically flood-prone area. During the hurricaneinduced flooding of 2004, the river swelled so high that it destroyed the homes that had once stood along the bank. FEMA funding allowed the town to buy out the 4.5-acre property, and in 2013 the park was created to provide floodwater storage to protect against future flooding — recreation is just the park’s secondary purpose.
In 2015 and 2017, Haywood Waterways Association received nearly $75,000 in grants to create a master plan for the park and begin enacting a revegetation plan, which is perhaps the most important component of the master plan. So far, about $20,000 worth of plants have been installed, mainly red maple, sycamore and river birch trees that stand erect at intervals down the gently sloping



“They (the Town of Clyde) still want to do more to make this of course a floodplain, which is really the best use for the long term — erosion protection, as well as protection of downstream landowners from flooding,” said Haywood Waterways Association Executive Director Eric Romanizyn.
While the 2016 master plan says this should be accomplished through intensive planting of trees and shrubs, as well as a milkweed garden, river cane offers many of the same flood protection benefits as these other types of species. River cane, whose scientific name is Arundinaria gigantea, is a native species of bamboo that usually reaches 4 to 8 feet in height but can get up to 25 feet high.
Its roots hold soil in place to stop erosion, and its stalks and leaves slow floodwaters. It can help reduce stormwater runoff and filter pollutants. It provides shade that helps keep the river cool, and it adds habitat for aquatic organisms.
The river cane planting aims to bolster another important resource, too — Cherokee culture. For thousands of years, Cherokee artisans have been using the splintered outer bark of the river cane plant to make baskets that are today sold as works of art worth hun-
dreds of dollars apiece. Making the baskets is a long, involved process, and gathering the river cane is a significant part of that process, said Qualla Arts and Crafts Manager Vicki Cruz.
“You can’t just run to a patch and cut about 50 pieces of cane,” she said. “You have to kind of search through the cane patch to find the perfect size and width. It takes a while to go gather it. And then when you get it back home you’re kind of on a timeframe. You want to work it while it’s still green.”
So, the artist will promptly get to work cleaning, cutting, scraping and then dying the bark to the desired color using natural pigments from walnut, butternut and bloodroot.
It had other uses too. River cane was used to make arrows, blow guns, sleeping mats, food preparation mats, walls, spears and more.
“One historian called it the plastic of Southeastern Native Americans,” said Griffith.
But development and agriculture have made river cane increasingly rare. The only estimate available in scientific literature says that it’s decreased by 98 percent from historic levels, Griffith said. That’s largely because the plant prefers to grow F
in wide, natural floodplains, and those are the types of spaces most likely to be settled and cleared by European settlers — often, all the way to the water’s edge.
“They were just left over with little remnant patches on the edges of the stream courses,” said Griffith. “All the river cane patches that I’ve seen are bounded by a body of water on one side and a road, railroad or mowed field on the other side, so just this thin strip is all that’s left.”
New river cane plantings can take years to establish, and because scientists still don’t understand the species’ flowering schedule, seeds are hard to find. Most plantings involve digging up heavy root balls from existing growth and transplanting them in a new location.
That’s what the volunteers on site Jan. 29 were there to help do. A year ago, Warren Wilson College was performing a stream restoration project that required them to get rid of a stand of river cane, and they sent three trailer-loads of the uprooted plants to the Eastern Band of Cherokee Indians. Employees at the tribal greenhouse stuck them in the ground with the goal of creating a nursery site from which the tribe could distribute plantings across the region as the stand expands and grows.
there are a few stems of harvestable river cane across the street from the Cherokee High School,” said Griffith. “I coordinated that effort with the help of over 100 volunteers over a decade ago, and just now those plants are coming to a stage where they could be harvested.”
There are also some river cane plantings at Western Carolina University, and students do a variety of studies on them as part of WCU biology classes. Loran Berg, collections manager for the university’s Mountain Heritage Center, was at the Jan. 29 event to get some ideas for a river canefocused exhibit that the center hopes to cre-

A $3,600 grant from the Cherokee Preservation Foundation allowed Haywood Waterways to receive clumps of the cane for planting at Rivers Edge Park. Town of Clyde employees came out with heavy machinery to dig planting holes, but helping hands were still needed to break up the giant clumps into separate chunks, wrestle them into the holes, and cover them with dirt.
“It’s a resource we need to preserve, not only for the Cherokee because it’s a native plant they use a lot, but it’s also something we should see in our environment,” said Bethel resident Kent Stewart, one of the 14 volunteers who came out to help.
However, Griffith warned, it’s highly likely that for years to come, the cane plantings will continue to look decisively unimpressive. A healthy river cane will have a roughly equal amount of mass belowground as it does aboveground, but even the most careful transplanting requires breaking off some of those lifegiving roots. So, a newly transplanted river cane plant will often spend years working on its underground root system before it sends up any new shoots. Sometimes, the transplanting process is taxing enough that even existing shoots will die off afterwards — but underground the plant is still alive and well.
“Other restorations I’ve done, the plants sat there for years. But now after 11 years

ate later this year.
The idea sprang from the Smithsonian Institution traveling exhibit “Roots of Wisdom: Native Knowledge and Shared Science” that WCU will host from March 15 through Aug. 22. The exhibit talks about the EBCI and the RTCAR program Griffith oversees, which aims to supply Cherokee artisans with the natural products they need to create traditional crafts.
“We decided to expand on that for an exhibit and do our own little complimentary exhibit to go along with that,” said Berg. “And after the Smithsonian exhibit goes to the next venue, which is up in Tennessee I believe, we’re going to have ours. After a few months I’m going to turn it into a traveling exhibit that can go around to other cities and schools, libraries. There’s a lot of excitement for river cane.”
That excitement is good for crafters, said Cruz, and for Cherokee culture.
“A lot of people are fixing areas because it was all taken out when there was land development and all that, but a lot of people know the importance of it, so they’re trying to preserve it and restore it,” she said. “The Cherokee play a big part in knowing what’s good, when to gather and just the importance of it.”















A new professional outdoor industry certificate will be available through the Western Carolina University Office of Professional Growth and Enrichment this spring via an online course.










“This new, one-of-a-kind professional online certificate program taps into a key strength and economic growth area in Western North Carolina and nationwide: human desire to be in the great outdoors,” said Andy Coburn, a member of WCU’s research and graduate faculty and one of two faculty liaisons to the outdoor industry.
Participants will learn the skills and information they need to grow their busi-
nesses, sharpen their leadership skills, design and develop unique outdoor products, and shape the future of the outdoor industry. Two tracks will be offered: small business/entrepreneurship and leadership. To earn the certificate, participants must take five core courses from their chosen track and choose three electives from a selection of leadership, communication, business and entrepreneurial workshops. Registration is $129 per workshop or $825 for the entire certificate program. Contact Jill Thompson for more information at jcthompson@wcu.edu or 828.227.7297. pdp.wcu.edu.
A game of glow-in-the-dark disc golf will commence at 6:30 p.m. Saturday, Feb. 6, at the Waynesville Recreation Park.
The disc golf course begins in front of the Waynesville Recreation Center at
will not accept walk-up guests.










Cataloochee Ski Area is operating on a reservation-only system due to high demand and COVID-19 protocols.
Guests must book lift tickets and rentals online, and some days are sold out. Once a given day is sold out online, Cataloochee
Tickets may be purchased up to two weeks in advance, and the lift ticket time starts when it is first scanned at the lift, not at the time of purchase. Lessons are available. Face coverings are required in lines, buildings, or when social distancing is not possible, and guests who decline to wear a face covering will be asked to leave. www.cataloochee.com.
A proposal to embark on a timber management project in the Nantahala National Forest spanning the next 10 years is open for public comment through Feb. 26.
The project would take place across a wide range of areas and forest conditions in Cherokee, Clay, Jackson, Graham, Macon and Swain counties, with no treatments implemented within the one-mile Trail of Tears National Historic Trail management corridor unless authorized through consultation with tribal governments.
Treatments would include:
n Crown-touch release of approximately 70 desirable trees per acre through manual or chemical treatment of non-desirable trees that are in direct competition for growing space.
n Release treatments using chemical or mechanical means to provide growing space for desired individual trees and tree species.
n Chemical and/or mechanical control of vine species where vines inhibit the growth and vigor of the surrounding vegetation.
n Plant native trees to improve species composition.
n Increase diffused light conditions in the understory to release young oaks, by mechanically removing the mid-story.
n Spray saplings in harvest unit skid trails
post-harvest with herbicide to extend the time that grasses and forbs occupy these sites for turkey, ruffed grouse, goldenwinged warbler and other species.
n Plant herbaceous species in log landings, openings and along roadways, especially those that benefit pollinators to provide foraging habitat for insects, birds and other wildlife.
n Use mechanical thinning of white pine and release of hardwoods and southern yellow pines to restore native forest communities in areas that were converted to white pine plantations.
n Treat areas infested with root rot using biological fungicides or similar products.
n Promote natural regeneration of native trees by heavily thinning damaged, degraded or poorly stocked stands.
n In riparian areas, release individual trees from competition where hemlock was abundant and/or regeneration potential is low due to an overabundance of shrubs. This could be accomplished through mechanical or chemical means, with supplemental tree plantings.
The proposed project would seek to accomplish a variety of environmental goals, including encouraging mast-producing species like oaks, restoring native species diversity, promoting the vigor of
trees in the 21-50-year class, mitigating the negative impacts of vines, restoring commercial white pine plantations to more natural species compositions, promoting tree growth in riparian areas where hemlock has been lost, promoting habitat for wildlife species and increasing the diversity of tree age, structure and habitat.
Comments identifying issues, concerns or opportunities associated with the project are due by the close of business on Feb. 26, and an additional 30-day comment period will open when the draft programmatic environmental assessment is complete. Only those who respond to this round of request for comments will remain on the mailing list for this project.
Submit comments to SM.FS.R8nctuscom@usda.gov or mail them to c/o Steverson Moffat, Planning Team Leader, Nantahala National Forest, 123 Woodland Drive, Murphy, NC 28906. State “Nantahala National Forest Stand Improvement EA” in the subject line when providing electronic comments, or on the envelope when replying by mail.
For questions related to the proposal, contact Steverson Moffat, Nantahala National Forest NEPA Planning Team Leader at smoffat@fs.fed.us or 828.837.5152, x108.

A class focused on improving health through improving cooking will be held 11 a.m. to 1 p.m. every Wednesday through March 24 via Zoom.
Fast food is less nutritious than meals prepared at home, but cooking often drops to the bottom of the daily priority list. The Cook Smart Eat Smart Cooking School with instructor Julie Sawyer will focus on meal preparation from start to finish using basic equipment, simple ingredients and healthy cooking techniques.
Sawyer is a Family & Consumer Sciences Agent with Haywood County Cooperative Extension and will be joined by fellow agents from neighboring counties. Free. Register at go.ncsu.edu/virtualcses. Contact Sawyer with questions at 828.456.3575 or Julie_sawyer@ncsu.edu.






















Friends of DuPont Forest will receive 100 free hours of public relations and marketing services thanks to the Stand Up Initiative, launched by Darby Communications in 2016.
The initiative is now a team effort from Darby Communications and Status Forward, and the agencies will help Friends of DuPont with its Share the Trails campaign. The campaign aims to address user conflict and harmonization on the trails, as DuPont State Recreational Forest attracts more than 1 million hikers, mountain bikers, trail runners, equestrians and other visitors every year. The effort will include a mix of social media assessment and strategy, website and wayfinding design support.
“We are so excited to be selected for the Stand Up Initiative,” says Sara Landry, Executive Director of Friends of DuPont. “The Share the Trails campaign will teach visitors how to be good guests — we believe a little education can go a long way to help protect the Forest and really enhance recreation for everyone.”
Past recipients of the Stand Up Initiative’s services include the San Juan Mountains Association, the NantahalaPisgah Forest Partnership, Bee City USA, Grand Staircase Escalante Partners and more. In addition to Friends of DuPont, California-based Waterside Workshops also received one of this year’s awards.
The N.C. Arboretum in Asheville is offering a series of all-new Adult Education courses free for Arboretum Society members.
Classes range from bonsai curation to backyard birding to winter stargazing. Memberships start at $25 for students, $50 for individuals and $70 for a household. www.ncarboretum.org.
Friends of the Mountains-to-Sea Trail will hold its annual Gathering of Friends virtually this year, planning an event for Friday and Saturday, March 26-27.
Affectionately called the unGathering of Friends, the event will feature a Friday evening “members-only” celebration and happy hour for current members of Friends of the Mountains-to-Sea Trail. Saturday morning and afternoon will be open for all to learn about North Carolina’s 1,175-mile flagship trail.

While the event will be virtual, the agenda will be open and participatory. Learn more at mountainstoseatrail.org/event/virtualannual-meeting. Membership starts at $35.
• The Jackson County Board of Commissioners will hold a regular meeting at 1 p.m. Feb. 16, at the Justice & Administration Building, 401 Grindstaff Cove Road, Room A201, Sylva.
• Papertown Spring Market will take place 9 a.m. to 3 p.m. Saturday, March 13, at Bethel Christian Academy, 100 Park St. There will be local vendors and food. Admission is free. For vendor information contact Jessica Jones 828.734.9733.
• Macon County non-profit organizations have until Feb. 26, to apply for county funds through the Macon County Community Funding Pool. Application forms and instructions are available on the Macon County website, www.maconnc.org. Hard copies are available at Macon County Public Library on Siler Farm Road in Franklin, the Hudson Library on Main Street in Highlands, and the Nantahala Public Library on Nantahala School Road.
• The Main Street Sylva Association is organizing a Spring Sylva Sidewalk Sale from 11 a.m. to 4 p.m. on Saturday, Feb. 27 in downtown Sylva. There will be live music on Main Street from 12:30-2:30 p.m., provided by the jazz trio "We Three Swing." There will also be live music at the Jackson Arts Market (JAM).
• The Small Business Center at Haywood Community College is offering a free "Empowering Mountain Food Systems - Agribusiness" webinar series. The four-part series is designed to address the unique needs of current and prospective agribusinesses. Upcoming classes include Liability for On-Farm Visits will be held 9-10 a.m. Wednesday, Feb. 10. Farmland Transition will be held 9-10 a.m. Friday, Mar. 19. Agritourism will be held 9-10 a.m. Wednesday, April 28. Interested current and prospective agriculture-based businesses and entrepreneurs are welcome to register for a single session or all four. Visit SBC.Haywood.edu or call 828.627.4512 for additional information or to register today.
• The Small Business Center at Haywood Community College will offer a Free virtual "WordPress 101 Summit" 10 a.m. to noon and 1 to 3 p.m., Thursday, Feb. 11. The goal of this two-part workshop is to assist small business owners in getting comfortable setting up and building a basic WordPress website or Blog. Visit SBC.Haywood.edu or call 828.627.4512 for additional information or to register today.
• Southwestern Community College is offering “Digital Literacy” classes this spring through the College & Career Readiness Department. New classes are forming at the Jackson and Macon County Libraries as well as the SCC Jackson and Macon Campuses and Swain Center. Cost for the class is $125, but there is no fee for those who meet waiver requirements. Register at 828.339.4272.
• Local animal welfare group Hope for Horses is gearing up for a mini-fundraiser following the opening of its new Waynesville executive office. The mini-fundraiser offers for purchase tee shirts, masks, and tote bags, through Feb. 11. For more information on Hope for Horses, visit www.hopeforhorses.org or call 828.683.0160. To participate in the mini-fundraiser, visit www.bonfire.com/store/hope-for-horses.
• On Thursday, Feb. 25, Grace Church in the Mountains will host the drive-by "Pathways Empty Bowls Dinner” from 4:30 to 7:30 p.m., and local band Arnold Hill will livestream a performance from 6 to 8 p.m., for guests to enjoy at home with their soup. VIP tickets are $40, gener-
n All phone numbers area code 828 unless otherwise noted.
n To have your item listed email to calendar@smokymountainnews.com
al admission $25, and $15 for soup flight only. Tickets may be purchased online at www.haywoodpathwayscenter.org or by calling 828.246.0332, or in person at the HPC office located at 179 Hemlock Street, in Waynesville.
• Cook Smart Eat Smart classes will be held virtually via Zoom starting Feb. 3 and will be held each Wednesday from 11 a.m. to 1 p.m. through March 24. Register online through Eventbrite at go.ncsu.edu/virtualcses. For questions, call 828.456.3575 or email Julie_sawyer@ncsu.edu.
• The “Valentine Train: Wine & Rail Pairing Experience” will run from 10:30 a.m. to 3 p.m. Saturday, Feb. 13, departing from the Great Smoky Mountains Railroad depot in Bryson City. All passengers also receive souvenir stemless wine glasses. Age 21 and over only. For more information and ticket prices, call 800.872.4681 or go to www.gsmr.com.
• Elevated Mountain Distilling Co. will host a special Valentine’s Day dinner event at 6 p.m. Sunday, Feb. 14. Fresh as Can Bee Catering will provide a four-course meal for $75 per couple. Bohemian Jean will entertain guests during the dinner with live music. The price also includes a special cocktail. Reservation must be made by Feb. 7. Call 828.545.0969 to make a reservation.
Bardo Arts Center presents an opportunity to watch the documentary “Code of Freaks” on-demand from Feb. 21-24. Once you begin watching the documentary, you have 24 hours to finish. Watch on a browser or through the EventiveTV App. Learn more and pre-order your free ticket at arts.wcu.edu/codeofthefreaks.
• The Haywood County Arts Council’s “Winter Member’s Show” will be held Feb. 5-27 in the Gallery & Gifts showroom at the HCAC in downtown Waynesville. Original work for 24 local artisans. Free and open to the public. www.haywoodarts.org.
• Lazy Hiker Brewing (Franklin) will host Natti Love Joys (roots/soul) Feb. 6 and Scott James Stambaugh Feb. 13. All shows begin at 7 p.m. For more information and a complete schedule of events, click on www.lazyhikerbrewing.com.
• Lazy Hiker Brewing (Sylva) will host Natti Love Joys (roots/soul) Feb. 5 and Bridget Gossett Feb. 12. All shows begin at 7 p.m. Free and open to the public. For more information and a complete schedule of events, click on www.lazyhikerbrewing.com.
• Balsam Falls Brewing (Sylva) will host an open mic from 8 to 10 p.m. every Thursday. Free and open to the public. www.balsamfallsbrewing.com.
• Nantahala Brewing (Sylva) will host live music semiregularly on the weekends. Free and open to the public. www.nantahalabrewing.com.
• There will be a free wine tasting from 6 to 8 p.m. every Thursday and 2 to 5 p.m. every Saturday at The Wine Bar & Cellar in Sylva. 828.631.3075.
• The Jackson County Coon Hunters Association will hold a night hunt and bench show on Friday, Feb. 6, in Sylva. The bench show will begin at 3 p.m. with field events at 5 p.m. and the night hunt starting at 6 p.m. The group will meet at 44 Oak Hill Drive. Contact Matthew Bryson, 828.508.6465 for more information.
• A four-part series of in-depth, hands-on agribusiness work sessions will begin at 4 p.m. Wednesday, Jan. 20, and repeat weekly through Wednesday, Feb. 10, at Southwestern Community College. These in-person classes will be held at SCC’s Burrell Conference Center. Free. Registration is required at bit.ly/3oMz1Io. Contact Tiffany Henry at 828.339.4426 or t_henry@southwesterncc.edu.
• Eric Romaniszyn, executive director of the Haywood Waterways Association, will lead a guided hike through the Rough Creek Watershed Saturday, Feb. 6. The hike is part of Haywood Waterways' “Get to Know Your Watershed” series of outdoor recreation events. The group will meet at the Lower Trail Junction parking lot at 9 a.m. The hike is free for HWA members with a $5 donation requested from nonmembers. Space limited to 10 hikers. RSVP to Christine O’Brien at christine.haywoodwaterways@gmail.com or 828.476.4667, ext. 11.
• The Blue Ridge Bartram Trail Conservancy is looking for youth ages 16 to 18 to fill six paid trail crew positions this summer, with a few upcoming events planned to give teens a taste of what their summer could look like. An online information session will be held at 4 p.m. Tuesday, Feb. 9. A volunteer workday open to teens ages 15 to 18 will be held 9 a.m. to 1 p.m. Saturday, Feb. 13. For more information, contact jennifer.love@macon.k12.nc.us.
• A new photography exhibit will open at the N.C. Arboretum in Asheville Jan. 16. On display at the Baker Exhibit Center through May 2, “The Enveloping Landscape” shows Patrice’s photographs alongside those of 25 workshop participants. Free with regular Arboretum admission.
• Help combat invasive species at Island Park in Bryson City during a pair of workdays scheduled for 11 a.m. to 2 p.m. Saturday, Feb. 6, and Wednesday, Feb. 10. Register at www.mountaintrue.org/event.
• The annual Haywood County Extension Master Gardener plant sale is underway, with edibles like berries and asparagus and hard-to-find native plants including pollinator-attracting perennials available at exceptional prices. Orders must be placed and pre-paid by March 1. Order forms are available online at www.haywood.ces.ncsu.edu or by email to mgarticles@charter.net. 828.456.3575.
• A recreational racing program will offer skiers and snowboarders of all abilities the chance to push their speed with weekly competitions on non-holiday Saturdays through the end of the season at Cataloochee Ski Area. Races run 9 to 11 a.m. and are subject to weather and slope conditions. Cost is $10 for two runs or $20 for unlimited pass, with a lift ticket or season pass required to participate. Register at the tickets center, and pre-register with NASTAR at www.nastar.com.
• The Pisgah Center for Wildlife Education near Brevard is now offering virtual education programs for students in public, private and homeschool. The free programs are tied to the N.C. Essential Standards for Science curriculum and led by an education specialist from the N.C. Wildlife Resources Commission. Class dates and times are flexible to meet classroom needs. To schedule a program, educators can contact 828.877.4423.
Visit www.smokymountainnews.com and click on Calendar for:
n Complete listings of local music scene
n Regional festivals
n Art gallery events and openings
n Complete listings of recreational offerings at health and fitness centers n Civic and social club gatherings
• A series of horticulture classes aimed at home gardeners will be offered in the New Year through Haywood County Cooperative Extension. Planned sessions are: Feb. 17, Lawn & Weeds; March 2, Introduction to Home Food Preservation; March 18, Landscaping with Native Plants; April 13, Pruning Trees & Shrubs. Classes, taught by extension agents and experienced Master Gardener volunteers, will last for approximately two hours and be held via Zoom until face-to-face training is possible. Sign up by emailing mgarticles@charter.net. Cost is $10 per class.
• The Assault on BlackRock trail race is set for Saturday, March 20, next year, and proceeds will benefit the Southwestern Community College Student Emergency Fund. Registration is $25 in advance or $30 on race day. The Student Emergency Fund proceeds will benefit helps SCC students who encounter unforeseen financial emergencies. Register at www.ultrasignup.com.
• The Nantahala Hiking Club will take a moderate 4mile hike, elevation change 800 feet, from Winding Stair north to a view from Panther Gap on the Appalachian Trail on Saturday, Feb. 6. The club will meet at Westgate Plaza in Franklin at 10 a.m. Call Leader Katharine Brown, 421-4178, for reservations. Visitors are welcome.
• The Nantahala Hiking Club will take a moderate 4mile hike, elevation change 400 feet, in the Jack Rabbit Recreation Area in Clay County on Saturday, Feb. 13. The club will meet at Westgate Plaza in Franklin at 10 a.m. Call leader Gail Lehman, 524-5298, for reservations. Visitors are welcome.
• The Nantahala Hiking Club will take a moderate 3mile hike, elevation change 700 feet, on the Coweeta Lab loop on Sunday, Feb. 14. The club will meet at the Smoky Mountain Visitors Center on Hwy. 441 at 1 p.m. Call leader Katharine Brown, 421-4178, for reservations. Visitors are welcome.
• The Nantahala Hiking Club will take moderate 6-mile hike, elevation change 900 feet, to William's Pulpit on the NC Bartram Trail on Saturday, Feb. 20. The club will meet at Westgate Plaza in Franklin at 10 a.m. Call Leader Gail Lehman, 524-5298, for reservations. Visitors are welcome.
• The Nantahala Hiking Club will take a “Full Moon” moderate 4-mile hike to Siler Bald, elevation change 700 feet, on Saturday, Feb. 27. The club will meet at Westgate Plaza in Franklin at 4:30 p.m. Call Leader Katharine Brown, 421-4178, for reservations. Visitors are welcome.
• The Nantahala Hiking Club will take a moderate 4mile hike, elevation change 300 feet, off the old Murphy road on Forest Service road 7281 on Sunday, Feb. 28. The club will meet at Westgate Plaza in Franklin at 2 p.m. Call Leader Kathy Ratcliff, 526-6480, for reservations. Visitors and friendly dogs are welcome.
The Smoky Mountain News Marketplace has a distribution of 16,000 copies across 500 locations in Haywood, Jackson, Macon and Swain counties, including the Qualla Boundary and west Buncombe County. Visit www.wncmarketplace.com to place your ad!
• $15 — Classified ads that are 25 words, 25¢ per word after.
• Free — Lost or found pet ads.
• $6 — Residential yard sale ads.*
• $1 — Yard Sale Rain Insurance Yard sale rained out? Call us by 10a.m. Monday for your ad to run again FREE
• Legal N otices — 25¢ per word
• $375 — Statewide classifieds run in 170 participating newspapers with 1.1+ million circulation. (Limit 25 words or less)
• Boost Online — Have your ad featured at top of category online $4
• Boost in Print
• Add Photo $6
• Bold ad $2
• Yellow, Green, Pink or Blue Highlight $4
• Border $4
Note: Highlighted ads automatically generate a border so if you’re placing an ad online and select a highlight color, the “add border” feature will not be available on the screen.
Note: Yard sale ads require an address. This location will be displayed on a map on www.wncmarketplace.com
p: 828.452.4251 · f:828.452.3585 classads@smokymountainnews.com www.wncmarketplace.com
For court-involved youth in Jackson County, funds available $128,439. Applications due to Heather Baker at the Jackson County Administration p.m., Tuesday, Marchtact Heather Baker at questions.
ONLINE ONLY AUCTION, Metal Working Equipment, Tools, Trucksham Industrial Dr. Denton, NC, Begins Closing 2/9
at 2pm, See Website for Inspections, ironhrseaucNCAL 3936
PROJECT ASSOCIATE: PART-TIME, FLEXIBLE, REMOTE -
Would you like to teachskills and contributing toprotects, and promotes culture & heritage on traditional lands of the Cherokee. We are a
offer ample variety to theorganized, and a strong communicator to assist remotely. Candidateser’s license and reliable vehicle, Strong internet connection, Ability to stay organized and on time
resume’, cover letter, and
JACKSON COUNTY PARKS AND RECREATION Is recruiting for
and perform daily trash pick-up of the parks and restrooms. This emgeneral duties such as basic plumbing, general repair, painting, landother duties as needed. Friday through Monday, High School Diploma or GED required and possess a valid NC Driver






sign-on bonus for Bellman, Housekeeping and Dishwashing!
FOR: Bellman, Dishwasher, Housekeeper, Turndown Attendant, F&B Manager In Training, F&B Asst. Manager, AM Line Cook, Cook, Pastry and Bread Cook, Servers, Bussers, Host/Hostess, Cosmetologist, Front Desk, Night Audit, Fitness Manager, PT Graphic Designer.
offered after 90 days employment. Apply online at oldedwardsinn.com/careers


one year of landscaping or general maintenance
submit an Application for Employment to the Sylva branch of the NCWorks Career Center or the Jackson County Huorg/employment-oppor-
THE JACKSON COUNTY DEPARTMENT
Of Social Services is recruiting for a Community Social Services Assistant. Duties primarily involve transporting foster children for a variety of purposes such medical appointments, counseling, education, or training. Candidates for this position should be highly dependable, adaptable, have the ability to lift children and car children, have completed high school, and have a valid NC driver’s licensecord. The starting salary is $24,168.16. Applicants should complete an application for Jackson
submit it to the Jackson County Department of
or the Sylva branch of the NCWorks Career Center.
and manage the Head Start/Early Head Start
Jackson Counties for eligible children and their families as authorized by the Administration for Children and Families and the Department of Health and Human Services. Seek funding to children and families and manage those programs as required by the funding source. Minimum degree in Early Childhood Education or related management, and administration. Have ability



years’ Early Childhood





Homes and Gardens Real Estate- Heritage
• Carolyn Lauter - carolyn@bhgheritage.com

Beverly Hanks & Associates- beverly-hanks.com
• Billie Green - bgreen@beverly-hanks.com
• Michelle McElroy- michellemcelroy@beverly-hanks.com
• Brian K. Noland - brianknoland.com
• Anne Page - apage@beverly-hanks.com
• Jerry Powell - jpowell@beverly-hanks.com
• Catherine Proben - cproben@beverly-hanks.com
• Ellen Sither - ellensither@beverly-hanks.com
• Mike Stamey - mikestamey@beverly-hanks.com
• Karen Hollingsed- khollingsed@beverly-hanks.com
• Billy Case- billycase@beverly-hanks.com
• Laura Thomas - lthomas@beverly-hanks.com
• John Keith - jkeith@beverly-hanks.com
• Randall Rogers - rrogers@beverly-hanks.com
• Susan Hooper - shooper@beverly-hanks.com
• Hunter Wyman - hwyman@beverly-hanks.com
• Rob Roland - robroland@beverly-hanks.com
ERA Sunburst Realty - sunburstrealty.com
• Amy Spivey - amyspivey.com
• Rick Border - sunburstrealty.com
• Steve Mauldin - smauldin@sunburstrealty.com
Jerry Lee Mountain Realty
• Jerry Lee Hatley- jerryhatley@bellsouth.net
• Pam James - pam@pamjames.com
Keller Williams Realty - kellerwilliamswaynesville.com
• The Morris Team - www.themorristeamnc.com
• Julie Lapkoff - julielapkoff@kw.com















• Darrin Graves - dgraves@kw.com Lakeshore Realty
• Phyllis Robinson - lakeshore@lakejunaluska.com Log & Frame Homes - 828-734-9323
Mountain Dreams Realty- maggievalleyhomesales.com
Mountain Creek Real Estate
• Ron Rosendahl - 828-593-8700
McGovern Real Estate & Property Management
• Bruce McGovern - shamrock13.com
RE/MAX Executive - remax-waynesvillenc.com remax-maggievalleync.com
• The Real Team - TheRealTeamNC.com
• Ron Breese - ronbreese.com
• Landen Stevenson- landen@landenkstevenson.com
• Dan Womack - womackdan@aol.com
• Mary & Roger Hansen - mwhansen@charter.net
• Juli Rogers - julimeaserogers@gmail.com
• Amy Boyd Sugg - amyboydsugg@gmail.com
• David Willet - davidwillet1@live.com
WNC Real Estate Store
• Melanie Hoffman - mhoffmanrealestate@gmail.com
• Thomas Hoffman - thoffman1@me.com


84Inflated self
ACROSS
1TV ET from Melmac
4Puncturing tool
7Restrained like Rover
15"To a ..." poems
19Road gunk
20Zodiac beast
21Course taker, e.g.
22Actress Carter
23Start of a riddle
26Singer Fitzgerald
27Grove sight
28Certain boxing stat
29Mil. bigwig
30Pale-looking
31Riddle, part 2
38Kilmer of film
40Alley- --
41Lion's foot
42Fellow's wig
43Actor Estevez
45Sega's hedgehog
47Look up to
51Riddle, part 3
55Lyric-writing Gershwin
56Globes
57"Ixnay"
58"Take this"
59Brainstorms
61Parsley bit
64Riddle, part 4
67Kay Thompson title girl
70Native Kiwi
71Fluctuated greatly
72Riddle, part 5
75Odor
77French port in Brittany
78Outing ruiner
79Afflicted
80Poses
85Riddle, part 6
90TV talker Phil
93Slipknot loop
94Andress of "Dr. No"
95Highest volcano in Eur.
98Mil. bigwig
99Mumbai "Mr."
100Cotillion girl
101End of the riddle
107Throat affliction, for short
108To the -- degree
109Western Hemisphere gp.
110McEntire of song
113Hair removal brand
114Riddle's answer
120Deli sandwiches, for short
121Grow pale
122Oct. follower
123O'Hare approx.
124Anatomical sac
125Slammer
126Porker's place
127Water barrier
DOWN
1Element statistic: Abbr.
2Oz lion player Bert
3Ascend a rock face without aids for support
4Done in the style of
5Vanished as if by magic
6Tilt the head skyward
7Big Brit. lexicon
8Houston-to-Dallas dir.
9Actress Nicole -- Parker
10Vowel sound in "game"
11Born first
12Alicia of ballet
13Use stitches
14"-- a Rebel"
15Like a single-part process
16City of India
17Barkin of "The Fan"
18Street talk
24Prefix with colonialism
25Auction unit
30Mars, to the Greeks
32Move around in confusion
33Pleistocene, for one
34Spout off
35Axis-vs.-Allies event
36Singer Tina
37Copycatted
38Bill blocker
39Eros, to the Romans
44Young girls
45Hang-up
46Be logically connected
48Letters after "had a farm"
49Ache for
50Subdued with a shock
52Lead-in to lateral
53Classic soda brand
54Coach Parseghian
59Very hot star
60Anti-alcohol measures
62Oct. exam for many juniors
63Home: Abbr.
64Compound in wine
65Greedy type
66Indigo, e.g.
67Fix firmly
68One of the Florida Keys
69Cineplex -- (former theater chain)
70Hurt severely
73Following loyally
74Zodiac beast
75Plum used to flavor gin
76Roman 1,051
79Commercial lead-in togram or -matic
81Shivered in fear or revulsion
82Frilly veggie
83Wild guess
85Lewis of rock
86Apt to pry
87Artist Vincent van --
88Master marksman
89Actress Moran
91Calvin Coolidge's college
92Beginning of a web address
96Papal envoy
972017 World Series winners
99Gives rise to
101Rachel Maddow's channel
102Rome's land
103Ground corn dish
104Burn -- in one's pocket
105Chili holder
106Foul up
111Version being tested
112Eden evictee
114"I'm less than impressed"
115"Who am -- argue?"
116Cave in
117Siouan people
118A small number of 119Trellis plant
have an automobile and the ability to travel on the local and national level. A completed application
be contacted if selectedground checks, drug test and motor vehicle org EOE/AA Pets
USE TONEKOTE For Cats & Dogs to stop shedding, scratching and coat!!! N.C. Clampitt
SAVE YOUR HOME! Are you behind paying your bank threatening fore-FREE CONSULTATION

FURNISHED ROOM FOR RENT Furnished
bath. Share our home for -
VACATION RENTAL
WANTED Senior Couple (no pets, no children, norooms in or near Waynesville for July and August.
IS YOUR HOME SMART YET? Get a FREE quote from Vivint, the #1 Home-Automation Company! Fast & Affordable! -
Financial and Tax
ATTENTION: AUTO INJURY VICTIMS If you have suffered a serious TAX PROBLEMS- Be -
levies, liens & audits, unFor Sale
MILITARY SURPLUS Jackets. Military Boots ON SALE. Cold Weather Clothing, Field Gear,
ENJOY 100% GUARANTEED, Delivered to the door, Omaha Steaks! Get
4 Free Chicken Breast. Order the Omaha Steaks Classic- only $129.99 Call -
BANKRUPTCY RELIEF! Help stop Creditor Harassment, Collection Calls, Repossession and Legal Actions! Speak to a
Here’s How It Works: Sudoku puzzles are formatted as a 9x9 grid, broken down into nine 3x3 boxes. To solve a sudoku, the numbers 1 through 9 must fill each row, column and box. Each number can appear only once in each row, column and box. You can figure out the order in which the numbers will appear by using the numeric clues already provided in the boxes. The more numbers you name, the easier it gets to solve the puzzle!

Answers on 26
· BY SUSANNA SHETLEY ·
Katy Gould is the director of the Small Business Center at Haywood Community College. She enjoys working with small business owners throughout the life of their business. Katy is also a busy wife, mom, adventurer and community citizen.
Rumble: When it comes to interviewing for a new job, what are your top tips?
Katy: A business or organization looking to start the hiring process has defined the role they are looking to fill through the job description posted. The description outlines the roles and responsibil-
skillset and/or experience align as a solution or fit to address this need for the business or organization.
Lastly, take the time to really get to know the company. Look into its mission, vision, and values. A greater understanding of the organization will not only assist in preparing you to answer interview questions but will assist you in getting to know the company culture, to make sure that it is a good fit for you.
Now, prep. Write potential interview questions, sketch your answers and practice answering them. Ask a friend or mentor to interview you via Zoom and provide feedback.
Rumble : If someone is hoping to start their own business, what is the first step?
Katy : Check yourself, revisit your passion and your why! It may seem counterintuitive to look inward before looking to the market; however, you are the business owner. You are the heart, soul, and face of the business! If the business isn’t something that you are passionate about, it will become increasingly difficult to log the time and energy needed to successfully launch.

ities of the position; and the skills, certifications, and experience necessary. This is a great place to start. Clearly, the posting spoke to you, and more than likely you have the qualifications required for the position. Now, begin to look at the hiring process through the eyes of the company. I like to approach it from a problem-solution/fit mindset. In other words, I begin to look for the value drivers behind the expressed need and see how my personal
If you are ready to press go, “Get Connected! North Carolina” is home to one of the most extensive small business development networks in the nation. From the N.C. Small Business Center Network, home to the HCC SBC, to the Small Business Technology Development Center and the Western Women’s Business Center, there are a multitude of organizations ready to assist you in navigating your small business journey. It doesn’t matter where you start. What is important is that you get in the pipeline, ask for help, and are ready to start planning!
Rumble : Due to the pandemic, folks have made the shift to working from home.
What are your productivity tips for people still working from home?
Katy : For those able to work from home, it is an amazing opportunity. It does, however, come with challenges.
Productivity from the home office may look a bit different than it did in the traditional office setting. First, the home place can be distracting. I find that focusing on core concepts that we would use in the traditional office setting can just as beneficial in the virtual work environment –Connect, Time, and Vision.

Connect — Make a point to connect with your team, even if it is virtually. It could be a leadership group, a project team from work, or an industry association. will provide the opportunity to engage with those essential to your success. It will also help you feel more aligned with your work efforts and provide a platform for others to share in your success and provide ideas to help you be more creative. Time — Build your action plan for the day, schedule the big rocks, and set a timer. If your day starts at 8 a.m. let’s say you block 30 minutes to answer emails from the day before. Write it, schedule it, set a timer, and do just that. Yes, priority tasks will arise that will throw your schedule off, but I find focusing on a single task for a scheduled timeframe a great use of my time and extremely efficient to accomplish the tasks at hand.
Vision — Take time to dream! This is something that I lost sight of at the beginning of the pandemic. When I began to take time to dream again, I found myself more focused, engaged, and on a quest to meet my goals. Take a moment to set weekly, monthly, and quarterly success measures. Then step back and build the objectives and action items to support your goals.
Katy can be reached via email at kmgould@haywood.edu.
Editor’s note: For the complete version of this article, www.smokymountainnews.com/rumble/i tem/30710-expert-tips-from-one-career-woman-to-another

Rumble is a weekly e-newsletter created by women, for women and about women. It is published by The Smoky Mountain News and delivered to your inbox each Thursday. The goal is to offer readers a beautifully curated email that will inspire and motivate women to live their best lives. By hearing the challenges and successes of other women, we hope you will find an opportunity to live, love, learn and grow in your own unique way.
Get details on any property in the MLS. Go to beverly-hanks.com and enter the MLS# into the quick search.














